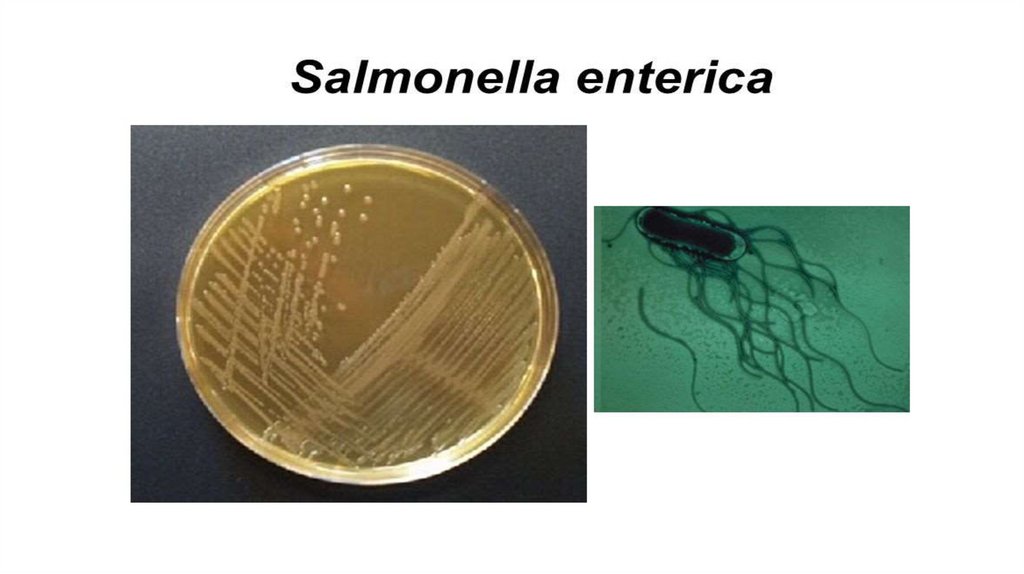

Similar presentations:
Диагностика и лечение кишечных инфекций
1.
Департамент образования и науки ТОГАПОУ ТО «Тюменский медицинский колледж»
ПМ.02 Осуществление лечебно-диагностической деятельности
Раздел 4. Обследование, диагностика и лечение пациентов с инфекционными и
паразитарными заболеваниями
Лекция №1
Тема : Диагностика и лечение кишечных инфекций.
Преподаватель:
Абдуллаева Гузель Урфатовна
2.
Диагностика и лечение кишечных инфекций.Кишечные инфекции - группа полиэтиологичных болезней с
различиями в эпидемиологии, но объединенные общей чертой –
первичной локализацией возбудителя в ЖКТ, что определяет
своеобразие фекально-орального механизма передачи возбудителя.
В структуре кишечных инфекционных болезней, с учетом резервуара и
источника возбудителя, выделяют кишечные антропонозы, зоонозы и
сапронозы, что необходимо учитывать при планировании и проведении
профилактической и противоэпидемической работы.
3.
Диагностика и лечение кишечных инфекций.Брюшной тиф (typhus abdominalis) - острое
антропонозное инфекционное заболевание,
вызываемое S. Enterica серотип Typhi,
характеризующееся лихорадкой, симптомами общей
интоксикации, бактериемией, язвенным поражением
лимфатического аппарата преимущественно тонкой
кишки, гепатолиенальным синдромом.
Механизм передачи: фекально - оральный
А01.0 – Брюшной тиф
4.
Диагностика и лечение кишечных инфекций.ЭТИОЛОГИЯ
Возбудитель относится к семейству Enterobacteriaceae, роду Salmonella, виду enterica,
подвиду I (enterica). Полное название возбудителя - Salmonella enterica serotype Typhi.
Биологические свойства возбудителя: Популяция штаммов Salmonella enterica
serotype Typhi включает подвижные грамотрицательные палочки, не образующие
споры. Относятся к факультативным анаэробам, хорошо растут на обычных
питательных средах.
S. Typhi относительно хорошо сохраняется при низких температурах, чувствительна к
нагреванию: при 56 °С погибает в течение 45–60 мин, при 60 °С — через 30 мин,
при кипячении — за несколько секунд (при 100 °С почти мгновенно).
Благоприятная среда для бактерий — пищевые продукты (молоко, сметана, творог,
мясной фарш, студень), в которых они не только сохраняются, но и способны к
размножению
5.
6.
Диагностика и лечение кишечных инфекций.ПАТОГЕНЕЗ
• Для патогенеза брюшного тифа характерны цикличность и развитие
определенных патофизиологических и морфологических изменений.
• Заражение происходит через рот, и первичным местом локализации
возбудителей оказывается пищеварительный тракт. Особо следует отметить, что
заражение не всегда влечет за собой развитие болезни.
• Возбудитель может погибнуть в желудке под влиянием бактерицидных свойств
желудочного сока и даже в лимфоидных образованиях тонкой кишки. Преодолев
желудочный барьер, возбудитель попадает в тонкую кишку, где происходят его
размножение, фиксация солитарными и групповыми лимфоидными
фолликулами с дальнейшим накоплением возбудителя, который по
лимфатическим сосудам проникает в мезентериальные ЛУ.
7.
Диагностика и лечение кишечных инфекций.ПАТОГЕНЕЗ
• Эти процессы сопровождаются воспалением лимфоидных элементов тонкой, а
нередко и проксимального отдела толстой кишки, лимфангитом и мезаденитом.
Они развиваются в течение инкубационного периода, в конце которого
возбудитель прорывается в кровяное русло, и развивается бактериемия, которая с
каждым днем становится интенсивнее. Под влиянием бактерицидных систем
крови лизируется возбудитель, высвобождаются ЛПС.
8.
Диагностика и лечение кишечных инфекций.КЛАССИФИКАЦИЯ
По формам течения:
1. манифестные формы
2. субманифестные (бессимптомные формы).
По клинической форме:
1. Типичная
2. Атипичная:
2.1. Стертая;
2.2. Абортивная.
3. Редкие формы (пневмотиф, менинготиф, нефротиф, колотиф, аппендикотиф,
холангиотиф, тифозный гастроэнтерит).
9.
Диагностика и лечение кишечных инфекций.КЛАССИФИКАЦИЯ
По тяжести течения:
1. Легкая
2. Среднетяжелая
3. Тяжелая
По длительности течения:
1. Циклическое
2. Рецидивирующее
По наличию осложнений:
1. Неосложненный
2. Осложненный :
– специфические осложнения (кишечное кровотечение, перфорация кишечника);
– неспецифические (пневмония, эпидемический паротит, холецистит, тромбофлебит, отиты
и др.).
10.
Диагностика и лечение кишечных инфекций.КЛИНИЧЕСКАЯ КАРТИНА
Инкубационный период от 3 до 21 дней (чаще от 9 до 14 дней, редко - до 60
дней) и зависит от инфицирующей дозы и состояния макроорганизма.
Различают следующие периоды болезни:
• Начальный
• Период разгара болезни
• Ослабления клинических проявлений (угасание)
• Выздоровления
11.
Диагностика и лечение кишечных инфекций.КЛИНИЧЕСКАЯ КАРТИНА
• Начало болезни при брюшном тифе постепенное или острое (более чем у 50% больных). Брюшной тиф
может начинаться по типу гастроэнтерита, псевдомалярийного приступа, менингита, заболевания
желчных путей, респираторного синдрома, катара верхних дыхательных путей.
При постепенном развитии температура тела и общая интоксикация нарастают медленно, появляются
недомогание, слабость, усталость, озноб, снижение аппетита вплоть до анорексии, головная боль,
нарушение сна, миалгии. В других случаях наблюдается подъем температуры тела до 38-390С в
течение 4–7 дней. Лихорадка постоянного типа, продолжительностью до 4–5 недель (температура тела
вначале невысокая, затем прогрессивно повышается, достигает к началу второй недели 38-390С,
становится постоянной (свидетельствует о выраженной токсинемии). Отмечается тошнота, дискомфорт
в области живота без четкой локализации (метеоризм и вздутие живота), возможны запоры, либо
поносы с характерным стулом ("гороховый суп (пюре)". К концу 1-й недели болезни головная боль
достигает максимума выраженности. Характерен внешний вид больного: адинамия, бледность кожных
покровов; кожа горячая, сухая. Может наблюдаться ангина. Язык утолщенный, обложен белым
налетом, с отпечатками зубов по краям ("тифозный язык"). Живот умеренно вздут .Иногда
наблюдаются выраженные боли в животе, симулирующие аппендицит. Со стороны сердечнососудистой системы в начальный период может отмечаться относительная брадикардия.
12.
Диагностика и лечение кишечных инфекций.КЛИНИЧЕСКАЯ КАРТИНА
• При остром начале болезни начальный период укорачивается, температура за 2 дня поднимается до
высоких цифр, сопровождается ознобом и быстро нарастает общая интоксикация, достигая
максимальной выраженности к 5-7-му дню болезни. Температура держится на высоких цифрах,
устойчива к специфической этиотропной терапии, чаще носит волнообразный характер.
Инфекционно-токсическая энцефалопатия ("тифозный статус") развивается у 20–46% больных,
тогда как у других больных наблюдаются его эквиваленты в виде головной боли, нарушения сна и
адинамии. Кожа ладоней и стоп желтушно окрашена (симптом Филипповича). С 8-9-го дня болезни
на кожных покровах появляется розеолезная экзантема (roseola elevata). Сыпь обычно скудная;
обильная - чаще при тяжелых формах болезни. Единичные розеолы чаще всего располагаются на
коже нижних отделов грудной клетки, спины, живота и очень редко на конечностях. В первые дни
появления розеолы бледные и сочные, контуры их довольно четкие, в последующие дни плоские, но
яркие. Продолжительность сохранения розеол составляет 2–4 дня (исчезают полностью или на
долгое время оставляют пигментацию). Характерно подсыпание розеол. Высыпания могут
наблюдаться в течение всего лихорадочного периода болезни, а иногда и при нормальной
температуре. При тяжелой форме сыпь может быть геморрагической, что является
неблагоприятным прогностическим признаком. Сыпь - опорный симптом при брюшном тифе,
встречается у 50–60% больных.
13.
Диагностика и лечение кишечных инфекций.КЛИНИЧЕСКАЯ КАРТИНА
В период разгара заболевания язык становится сухим, покрыт серым или коричневым налетом, иногда плотным
грязно-бурым налетом (фулигинозный язык). Наблюдается метеоризм, а также урчание и правой подвздошной
области. Стул чаще отсутствует, однако в ряде случаев может быть жидким до 4–5 раз в сутки, по типу горохового
супа. Печень и селезенка отчетливо увеличены. средней плотности. Отмечается гипотония, тоны сердца глухие,
наряду с относительной брадикардией у многих выявляется дикротия пульса. Изменения со стороны органов
дыхания характеризуются явлениями бронхита или пневмонии.
К концу 2-й недели болезни наступает фаза наивысшего развития болезни, которая длится около 2 недель.
Отмечаются выраженная интоксикация, затемненное сознание, бред, дрожание рук, судорожное подергивание
мимической мускулатуры, непроизвольное мочеиспускание и дефекация, снижение артериального давления,
сохраняется относительная брадикардия пульса, глухость тонов сердца.
В этот период болезни возможно развитие осложнений: носовые и кишечные кровотечения, перфорация язв
тонкой кишки, кроме того - пневмония, отит, миокардит, пиелит, менингит, инфекционный психоз и т. д.
При легком и среднетяжелом течении нарушения со стороны центральной нервной системы и сердечнососудистой выражены умеренно.
В разгаре болезни уменьшается количество мочи. Определяются протеинурия, микрогематурия, цилиндрурия.
Возникают бактериурия, которая может привести к воспалению почечных лоханок и слизистой оболочки
мочевого пузыря.
14.
Диагностика и лечение кишечных инфекций.КЛИНИЧЕСКАЯ КАРТИНА
В фазе угасания клинических симптомов температура постепенно снижается, чаще коротким лизисом, а затем
нормализуется. Улучшается самочувствие, появляется аппетит, исчезают вялость, головная боль, метеоризм,
очищается язык, уменьшаются размеры печени и селезенки, увеличивается диурез.
Период выздоровления начинается с нормализации температуры, восстановления нарушенных функций
организма. Продолжительность его составляет 2–3 недели в зависимости от тяжести болезни. Длительное время
могут оставаться астения, раздражительность, вегетососудистая дистония. В это время наблюдаются осложнения
в виде миокардита, тромбофлебита, остеомиелита, холецистита и т. д.
Период выздоровления длится течение 2–3 недели, возможно субфебрильная температура, как результат
вегетативно-эндокринных расстройств. У 3–5 % (до 12 % и выше по некоторым данным) формируется
хроническое бактерионосительство.
Однако, до нормализации температуры возможны обострения, которые характеризуются нарастанием лихорадки
и интоксикации, появлением свежих розеол, увеличением селезенки. Обострения наблюдаются чаще при не
правильном лечении, в том числе при использовании антибактериального препарата системного действия,
которому имеется устойчивость возбудителя.
Тяжесть болезни оценивается по степени интоксикации, по высоте и длительности лихорадки, по характеру и
количеству осложнений
15.
Диагностика и лечение кишечных инфекций.ОСОБЕННОСТИ ТЕЧЕНИЯ У ПАЦИЕНТОВ ПОЖИЛОГО
И СТАРЧЕСКОГО ВОЗРАСТА
У лиц пожилого и старческого возраста болезнь начинается медленнее,
тифозное состояние встречается реже, температура тела у подавляющего
большинства больных достигает 38 - 40ºС и держится дольше, чем у молодых
больных, но выше 40ºС обычно не повышается. У пожилых реже,
чем у молодых, встречаются спленомегалия, гепатомегалия, гиперемия зева,
экзантема, но чаще подсыпание новых элементов сыпи, запор и метеоризм.
Число брюшнотифозных больных с наличием экзантемы с увеличением
возраста больных уменьшается, но феномен ―подсыпания встречается чаще.
Это связано с менее интенсивным и неравномерным образованием антител, меньшей
реактивностью измененных кровеносных капилляров у больных пожилого и старческого
возраста по сравнению с больными молодого возраста.
16.
Диагностика и лечение кишечных инфекций.ОСОБЕННОСТИ ТЕЧЕНИЯ У ПАЦИЕНТОВ ПОЖИЛОГО
И СТАРЧЕСКОГО ВОЗРАСТА
Симптомы общей интоксикации у больных пожилого и старческого возраста
продолжаются дольше. Нарушения со стороны сердечно-сосудистой системы и органов
дыхания встречаются чаще, а бактериологическое очищение организма происходит
медленнее по сравнению с больными молодого возраста.
17.
Диагностика и лечение кишечных инфекций.ДИФФЕРЕНЦИАЛЬНАЯ ДИАГНОСТИКА БРЮШНОГО ТИФА
Нозологическая форма
Признак
Брюшной тиф
грипп
пневмония
Аденовирусная инфекция Милиарный туберкулёз
Малярия
Сезонность
летне-осенняя
зимняя
холодное время года
осенне-зимняя
отсутствует
май-сентябрь
Озноб
редко
часто
часто
не характерен
характерен
характерен
Головная боль
умеренная
сильная
умеренная
слабая
умеренная
сильная
Алгии
не характерны
выражены
умеренные
возможны
возможны
выражены
Длительность лихорадки
4-6 дней, 5-6 нед
до 5-6 дней
3-7 дней
3-14 дней
длительная
до 3-4 нед
Максимум лихорадки
(срок)
2-я неделя
1-2 дня
3-5-й день
не определен
не определен
во время приступа
Кашель
сухой, редкий
сухой, затем
продуктивный
сухой, затем продуктивный
сухой, продуктивный
сухой
не характерен
Одышка
не характерна
возможна
характерна
не характерна
характерна
во время приступа
Кожа лица
бледная
гиперемирована
гиперемирована
не изменена
бледная
гиперемирована во время
приступа
Конъюнктива, склера
не изменены
склерит, конъюнктивит
инъекция конъюнктив
плёнчатый конъюнктивит нет характерных изменений
склерит, конъюнктивит
Лимфоузлы
не увеличены
не увеличены
не увеличены
увеличены
возможна полиаденопатия
не увеличены
Физикальные данные
жёсткое дыхание,единичные сухие хрипы
жёсткое
дыхание,единичные
сухие хрипы
укорочение перкуторного звука, влажные хрипы, жёсткое дыхание, сухие
крепитация
хрипы
жёсткое дыхание,единичные
сухие и влажные хрипы
изменения не характерны
Частота сердечных
сокращений
относительная брадикардия
относительная
брадикардия
тахикардия
изменения не характерны тахикардия
тахикардия
Гепатоспленомегалия
типична
не наблюдают
редко
часто
возможна
постоянно
Картина крови
лейко- и нейтропения со сдвигом влево,
анэозинофилия, относительный лимфоцитоз
лейкопения, лимфоцитоз
нейтрофильный лейкоцитоз со сдвигом влево,
увеличение СОЭ
неспецифичная
неспецифичная
анемия, лейкопения
18.
Диагностика и лечение кишечных инфекций.ОСЛОЖНЕНИЯ.
Кишечное кровотечение чаще возникает в конце второй и на третьей
неделе болезни. Оно может быть профузным и незначительным в зависимости от
величины кровеносного сосуда, состояния свёртываемости
крови, тромбообразования, величины АД и т.д. В ряде случаев имеет характер
капиллярного кровотечения из кишечных язв.
При массивных кровотечениях может развиться геморрагический шок, что
имеет серьёзный прогноз. Наиболее опасны кровотечения из толстой кишки.
Кровотечения могут быть однократными и повторными — до шести раз и более,
из-за нарушений свёртываемости крови могут длиться по несколько часов.
Более грозное осложнение — прободение кишки, которое встречают у 0,5 8% больных. Наблюдения свидетельствуют, что зависимость между
анатомическими изменениями и тяжестью интоксикации отсутствует, поэтому
затрудняется возможность предсказать развитие перфорации. Чаще она возникает
в терминальном отделе подвздошной кишки.
Перфорации обычно бывают однократными, но встречают трёх- и пятикратные, и
возникают они чаще у мужчин.
19.
Диагностика и лечение кишечных инфекций.ОСЛОЖНЕНИЯ.
У 0,5-0,7% больных, как правило, в периоде разгара болезни развивается
ИТШ. Клиническую картину ИТШ характеризуют внезапное резкое ухудшение
состояния, озноб, гипертермия, спутанность сознания, артериальная гипотензия,
лейко- и нейтропения. Кожа становится бледной, влажной, холодной, нарастают
цианоз, тахикардия, развиваются ДН («шоковое лёгкое»), олигурия. В крови
отмечают азотемию (повышается концентрация мочевины и креатинина).
20.
Диагностика и лечение кишечных инфекций.ИСХОД
При современном уровне медицинской помощи прогноз при брюшном тифе благополучный, заболевание заканчивается полным
выздоровлением.
Критерии повышенного риска неблагоприятного исхода брюшного тифа:
• Госпитализация спустя 7 дней от начала болезни;
• Тяжелое течение брюшного тифа;
Признаки неблагоприятного течения:
• постоянный тип лихорадки;
• тахикардия;
• артериальная гипотензия;
• дистрофические изменения миокарда;
• анемия;
• лейкопения (менее 3∙109 в 1 мкл крови);
• лейкоцитоз (более 10∙109 в 1 мкл крови);
• возможное иммунодефицитное состояние и снижение резистентности организма, в т.ч. дефицит массы тела, частые затяжные
инфекции в анамнезе, конституциональные отклонения в развитии;
• Хронические сопутствующие заболевания и хроническая очаговая инфекция;
• Сочетанные инфекционные болезни.
21.
Диагностика и лечение кишечных инфекций.МЕТОДЫ ЛАБОРАТОРНОГО ИССЛЕДОВАНИЯ
Диагностика брюшного тифа основана на эпидемиологических, клинических
и лабораторных данных.
Клиническая диагностика
Из эпидемиологических данных существенны контакт с лихорадящими
больными, употребление необеззараженной воды, немытых овощей и фруктов,
некипячёного молока и молочных продуктов, приготовленных из него и
приобретённых у частных лиц, питание в предприятиях общественного питания с
признаками санитарного неблагополучия, высокая заболеваемость кишечными
инфекциями в месте пребывания больного. Из клинических данных наиболее
важны высокая лихорадка, розеолёзная сыпь, адинамия, характерный вид языка,
метеоризм, увеличение печени и селезёнки, задержка стула, заторможенность,
нарушение сна, головная боль, анорексия. Все больные с лихорадкой неясного
генеза должны быть обследованы амбулаторно на брюшной тиф.
22.
Диагностика и лечение кишечных инфекций.МЕТОДЫ ЛАБОРАТОРНОГО ИССЛЕДОВАНИЯ
Лабораторная диагностика
Наиболее информативный метод — выделение гемокультуры возбудителя. Положительный
результат может быть получен на протяжении всего лихорадочного периода, но чаще в начале
болезни. Посев крови следует производить в течение 2 - 3 дней ежедневно, первый раз —
желательно до назначения антимикробных препаратов. Со второй недели болезни вплоть до
выздоровления возможно выделение копро-, урино- и билиокультуры, однако при
положительном результате исследования нужно исключить возможность хронического
носительства. Исследование жёлчи проводят на десятый день после нормализации
температуры тела. Предварительный результат бактериологического исследования может быть
получен через двое суток, окончательный, включая определение чувствительности к
антибиотикам и фаготипирование, — через 4 - 5 сут.
Для подтверждения диагноза используют также РА (реакция Видаля), а также более
чувствительную и специфическую РНГА с Н-, О- и Vi-антигеном. Исследование проводят
при поступлении и через 7-10 сут. Диагностическое значение имеет нарастание титра Оантител в четыре раза или титр 1:200 и выше. Положительная реакция с Н-антигеном
свидетельствует о перенесённом ранее заболевании или вакцинации, с Vi-антигеном — о
хроническом брюшнотифозном носительстве. В последние годы для диагностики брюшного
тифа применяют также ИФА.
23.
Диагностика и лечение кишечных инфекций.ПРИНЦИПЫ НЕМЕДИКАМЕНТОЗНОГО И МЕДИКАМЕНТОЗНОГО ЛЕЧЕНИЯ.
Современное лечение больных брюшным тифом строят на комплексном применении этиотропной и
патогенетической терапии.
По федеральным стандартам, объёма медицинской помощи, оказываемой больным брюшным тифом,
средняя длительность госпитализации больных лёгкой формой составляет 25 дней, среднетяжёлой — 30
дней, тяжёлой — 45 дней.
Терапию больных брюшным тифом, в соответствии с федеральными стандартами, проводят по следующим
направлениям: антибактериальная, дезинтоксикационные и плазмозаменяющие растворы,
десенсибилизирующие средства, витаминотерапия, спазмолитики, биопрепараты, симптоматические
средства, аминокислоты, сахара и препараты для парентерального питания, гормоны и их аналоги (по
показаниям).
До шестого-седьмого дня нормальной температуры больному необходимо соблюдать постельный режим, с
седьмого-восьмого дня разрешают сидеть, а с десятого-одиннадцатого дня нормальной температуры при
отсутствии противопоказаний разрешают ходить.
Выписку переболевших из стационара производят после клинического выздоровления, но не ранее 21-23-го
дня с момента нормализации температуры и после получения двукратного отрицательного
бактериологического исследования кала и мочи и однократного — дуоденального содержимого.
24.
Диагностика и лечение кишечных инфекций.ПРИНЦИПЫ НЕМЕДИКАМЕНТОЗНОГО И МЕДИКАМЕНТОЗНОГО ЛЕЧЕНИЯ.
Основные направления терапевтических
мероприятий
Диетотерапия
Антибактериальная терапия
Иммунотерапия — по показаниям (длительное
бактериовыделение, обострения, рецедивы)
Дезинтоксикационная терапия — по показаниям
(тифозный статус, артериальная гипотензия,
гипертермия и другие проявления интоксикации)
Витаминотерапия, антиоксидантная терапия по
индивидуальным показаниям
Препараты
Весь лихорадочный период — стол 4А, затем 4, 2 и
13
В связи с широким распространением штаммов S.
typhi, устойчивых к хлорамфениколу, ампициллину,
котримоксазолу, препаратами выбора стали
фторхинолоны,
цефалоспорины.Антибиотикотерапию проводят до
10-го дня после нормализации температуры тела
Пентоксил, метацил, тимоген, брюшнотифозная
вакцина
Внутривенно раствор Рингера, 5% раствор глюкозы,
реополиглюкин, реамберин и др.
Аскорбиновая кислота , витамин Е, унитиол.
25.
Диагностика и лечение кишечных инфекций.ПРЕПАРАТЫ ВЫБОРА
26.
Диагностика и лечение кишечных инфекций.ОЦЕНКА ЭФФЕКТИВНОСТИ И БЕЗОПАСТНОСТИ ПРОВОДИМОГО
ЛЕЧЕНИЯ
Индикаторы эффективности лечения:
• купирование симптомов заболевания;
• купирование осложнений (при их наличии)
27.
Диагностика и лечение кишечных инфекций.ТАКТИКА ВЕДЕНИЯ ПАЦИЕНТОВ
Несмотря на планирование проведения диагностических и лечебных мероприятий пациентам при
брюшном тифе, помощь носит неотложный характер. Позднее начало комплексной терапии, в том
числе этиотропной, приводит к более длительному течению заболевания, к запоздалой
диагностике осложнений и может ухудшить прогноз болезни у конкретного больного.
Рекомендована госпитализация в инфекционный стационар всех пациентов с брюшным тифом
инфекционный стационар по клиническим и эпидемическим показаниям
Госпитализацию больных осуществляют в течение первых трех часов, в сельской местности в
течение 6 часов после получения экстренного извещения. На территориях с эндемичной
заболеваемостью брюшным тифом провизорной госпитализации подлежат лица с лихорадочным
состоянием невыясненного происхождения, продолжающимся более трех дней, с обязательным
исследованием крови на гемокультуру. Вновь поступивших больных размещают отдельно от
реконвалесцентов.
Рекомендовано врачу-инфекционисту произвести осмотр пациента с подозрением на брюшной тиф
не позднее 20 мин от момента поступления.
Реконвалесцентов брюшного тифа из стационара рекомендуется выписывать после исчезновения
клинических симптомов и отрицательного трехкратного микробиологическое (культуральное)
исследование кала, мочи и однократного исследования желчи на сальмонеллу тифа (Salmonella
Typhi), паратифа A (Salmonella Paratyphi A), паратифа B (Salmonella Paratyphi B), паратифа С
(Salmonella Paratyphi C]
28.
Диагностика и лечение кишечных инфекций.ТАКТИКА ВЕДЕНИЯ ПАЦИЕНТОВ
Первое исследование проводят спустя 5 дней после установления нормальной температуры, последующие - с
пятидневным интервалом. Желчь исследуется на 10 день нормальной температуры. Реконвалесцентов,
получавших антибактериальные препараты системного действия, выписывают из стационара не ранее 21 дня.
Лиц, не получавших антибактериальные препараты системного действия, - не ранее 14 дня после начала
апирексии. Обнаружение S.Тyphi в процессе контрольного (перед выпиской из стационара) лабораторного
обследования при отсутствии у больного, не относящегося к категории работников отдельных профессий,
производств и организаций, признаков болезни не является противопоказанием к выписке из стационара.
Обнаружение S.Тyphi в процессе контрольного лабораторного обследования при отсутствии у больного,
относящегося к категории работников отдельных профессий, производств и организаций, признаков болезни
является основанием для проведения повторного курса лечения. В случае продолжающегося выделения
S.Тyphi такой больной подлежит выписке из стационара с последующей постановкой на диспансерный учет с
указанием на бактерионосительство S.Typhi и отстраняется от работы.
Реконвалесцентов, не относящихся к "декретированной группе", у которых в процессе контрольного
лабораторного обследования диагностируется выделение S.Typhi, задерживают в больнице и проводят
дополнительный комплекс лечения. Если возбудитель продолжает регистрироваться через 1,5–3 месяц после
клинического выздоровления, реконвалесцента выписывают домой с указанием на бактерионосительство
S.Typhi. от работы не отстраняют.
Рекомендована после выписки из стационара реабилитация и диспансерное наблюдение реконвалесцентов
брюшного тифа в поликлинике по месту жительства.
29.
Диагностика и лечение кишечных инфекций..
ПОКАЗАНИЯ К ОКАЗАНИЮ СПЕЦИАЛИЗИРОВАННОЙ МЕДИЦИНСКОЙ
ПОМОЩИ В СТАЦИОНАРНЫХ УСЛОВИЯХ
К оказанию специализированной медицинской помощи в стационарных условиях
подлежат все пациенты имеющие наличие характерного эпидемиологического
анамнеза и клинических симптомов брюшного тифа.
100% госпитализация!
30.
Диагностика и лечение кишечных инфекций.Паратифы – инфекции тифо-паратифозной группы, протекающие с
температурной реакцией, интоксикационным синдромом, кожными
высыпаниями, диспепсическими расстройствами различной степени
выраженности.
Источник инфекции — только человек (больной (с 7-го
дня болезни) или бактериовыделитель). Возбудитель выделяется с
испражнениями и мочой. Бактериовыделение
бывает острым (не более 3 месяцев после клинического
выздоровления) и хроническим (пожизненным) — основной источник
тифо-паратифозной инфекции.
Механизм инфицирования — фекально-оральный.
Пути передачи: водный, пищевой и контактно-бытовой.
А01.1 – Паратиф А
А01.2 – Паратиф Б
31.
Диагностика и лечение кишечных инфекций.ЭТИОЛОГИЯ
Паратифозные
бактерии
Salmonella, возбудитель:
- паратифа А - S. paratyphi A;
-
самостоятельный
вид
микробов
рода
- паратифа В - S. schotmuelleri;
По форме, величине, тинкториальным свойствам они не имеют отличий
от брюшнотифозных; биохимически более активны, особенно S. schotmuelleri,
что находится в соответствии с меньшей патогенностью для человека. Возбудители
паратифов хорошо сохраняются во внешней среде, в том числе в питьевой воде,
молоке, масле, сыре, хлебе, относительно устойчивы к действию физических и
химических факторов, длительно сохраняются при низких температурах (во льду в
течение нескольких месяцев). При кипячении погибают мгновенно.
32.
Диагностика и лечение кишечных инфекций.ПАТОГЕНЕЗ
Патогенез паратифа А, В и брюшного тифа принципиальных различий не имеет.
При паратифах чаще, чем при брюшном тифе, поражается толстая кишка и
в меньшей степени выражены деструктивные процессы в лимфатическом
аппарате кишечника.
33.
Диагностика и лечение кишечных инфекций.КЛАССИФИКАЦИЯ
по этиологии – А,В,С;
по типу:
типичные;
атипичные.
типичные формы:
гастроинтестинальная;
тифоподобная;
септическая.
по тяжести:
легкая;
среднетяжелая;
тяжелая.
34.
Диагностика и лечение кишечных инфекций.КЛИНИЧЕСКАЯ КАРТИНА
Паратиф отличается от брюшного тифа более острым началом, сравнительно лёгким течением и меньшей
продолжительностью заболевания. Симптомы брюшного тифа и паратифов во многом сходны. Вместе с
тем при паратифе А инкубационный период короче, чем при брюшном тифе, и составляет в среднем 610 сут. Характерно острое начало заболевания с быстрым повышением температуры тела и наличием в
начальном периоде катаральных явлений - насморка, кашля.
Лицо больных гиперемировано, сосуды склер инъецированы, можно наблюдать герпетические высыпания
на губах и крыльях носа. Температурная реакция не столь постоянна, как при брюшном тифе, часто
принимает неправильный характер, а длительность её меньше. На высоте заболевания возможны озноб и
повышенное потоотделение.
Достаточно часто экзантема появляется рано (4-7-й день болезни). Помимо характерной розеолёзной сыпь
может быть кореподобной или петехиальной. Она более обильная и располагается не только на коже
живота и груди, но и на конечностях. Характерны полиморфизм высыпаний и «подсыпания» в динамике
заболевания. Чаще заболевание протекает в среднетяжелой форме, интоксикация выражена умеренно, а её
продолжительность меньше, чем при брюшном тифе. Так же, как и брюшной тиф, заболевание может
принять рецидивирующее течение.
35.
Диагностика и лечение кишечных инфекций.КЛИНИЧЕСКАЯ КАРТИНА
Инкубационный период при паратифе В обычно составляет 5-10 дней. Заболевание
начинается остро; характерно развитие гастроэнтерита с абдоминальными болями,
тошнотой, рвотой, послаблением стула и повышением температуры тела, что можно
ошибочно истолковать как начало пищевой токсикоинфекции. Температурная реакция
носит неправильный характер и относительно укорочена по времени. Так же, как при
паратифе А, сыпь может носить разнообразный характер, быть обильной и
располагаться не только на туловище, но и на конечностях. Чаще заболевание протекает
в среднетяжелой форме, однако известны случаи тяжёлого течения паратифа В с
развитием менингита, менингоэнцефалита и септикопиемии.
36.
Диагностика и лечение кишечных инфекций.ОСОБЕННОСТИ ТЕЧЕНИЯ У ПАЦИЕНТОВ ПОЖИЛОГО
И СТАРЧЕСКОГО ВОЗРАСТА
У лиц пожилого и старческого возраста болезнь начинается медленнее,
тифозное состояние встречается реже, температура тела у подавляющего
большинства больных держится дольше, чем у молодых
больных.
37.
Диагностика и лечение кишечных инфекций.ДИФФЕРЕНЦИАЛЬНАЯ ДИАГНОСТИКА ПАРАТИФА А и В
Диагноз
Обоснование для
дифференциальной диагностики
Сальмонеллез
тифоподобная
форма
Лихорадка, диарея
Инфекционный
мононуклеоз
Лихорадка,
гепатоспленомегалия
Иерсиниоз
Малярия
Обследования
Критерии исключения диагноза
Начало по типу острого гастроэнтерита, лихорадка
Бактериологическое исследование кала и неправильного характера, «тифозный статус» отсутствует,
серологическое исследование крови
гепатолиенальный синдром встречается не всегда
наличие атипичных мононуклеар более
10%, ИФА – анти ВЭБ IgM
Ангина, лимфоаденопатия (особенно шейных
лимфоузлов)
Полиморфизм клинических симптомов (поражение
Лихорадка, интоксикация,
суставов, скарлатиноподобная, реже пятнистоБактериологическое исследование кала и
гепатоспленомегалия, диарея,
папулезная сыпь на коже, симптом капюшона, перчаток и
серологическое исследование крови
полиморфная сыпь
носков, шелушение кожи, желтуха, гиперемия,
припухание ладоней и стоп)
Толстая капля крови на присутствие
Типичные приступы, сопровождающиеся ознобом,
Лихорадка
малярийных плазмодиев
жаром и потом.
Грипп
Лихорадка
Лептоспироз
Лихорадка
Рост заболеваемости в холодное время года, резкая
Мазок из носа на иммунофлюоресцентный
головная боль, кратковременная лихорадка (4-5 дней),
анализ
гиперемия лица, боли в глазных яблоках, мышцах,
Характерный эпиданамнез, бурное, внезапное начало
заболевания, боли в икроножных мышцах,
усиливающиеся при ходьбе, гиперемия, одутловатость
Бактериологическое и серологическое
лица, склерит, полиморфная экзантема на 3-6 день
исследование
болезни, артрит, желтуха, менингеальные знаки
положительны, поражения почек (олиго- или анурия,
положительный симптом Пастернацкого), в ОАМ
протеинурия, лейкоцитурия, микрогематурия.
38.
Диагностика и лечение кишечных инфекций.ДИФФЕРЕНЦИАЛЬНАЯ ДИАГНОСТИКА ПАРАТИФА А и В.
Аденовирусная
инфекция
Паратифы А и В
Сыпной тиф
Лихорадка, лимфоаденопатия
Мазок из носа на иммунофлюоресцентный
анализ
Осенне-зимняя сезонность, слабая головная боль, слабая или умеренно
выраженная интоксикация, выраженный и длительно сохраняющийся катаральный
синдром, сухой, продуктивный кашель, конъюнктивит, жесткое дыхание, сухие
хрипы.
Лихорадка, интоксикация,
Бактериологическое и
гепатоспленомегалия, диарея, сыпь серологическое исследование
Лицо гиперемировано, конъюнктивит, герпетические
высыпания на губах, лихорадка преимущественно
неправильного типа, розеолезная сыпь обильная, появляется
в первые 2-3 дня болезни
Лихорадка, интоксикация,
спленомегалия, сыпь
Острое начало с резкой головной боли, гиперемия лица,
инъекция сосудов склер, «меловой язык», раннее
увеличение селезенки, сыпь обильная, розеолезнопетехиальная (на сгибательной поверхности рук, груди и
животе), тахикардия, нервно-психическое возбуждение
Бактериологическое и
серологическое исследование
Энтеровирусная Лихорадка, интоксикация, диарея,
инфекция
сыпь
Нет выраженной интоксикации, отсутствует фулигинозный
язык, не всегда встречается гепатоспленомегалия, в
Кал на энтеровирусы методом ПЦР
зависимости от формы заболевания могут встречаться
герпетическая ангина, миалгия и другие симптомы.
Милиарный
туберкулез
Сезонность отсутствует, характерен озноб, умеренная
Бактериологическое исследование головная боль, полиаденпатия, в легких жесткое дыхание,
единичные сухие и влажные хрипы, тахикардия
Острый лейкоз
Лихорадка, лимфоаденопатия,
интоксикация
Лихорадка, лимфоаденопатия,
Биопсия костного мозга
гепатоспленомегалия, интоксикация (стернальная пункция)
Кровоточивость, слабость, утомляемость, склонность к
инфекциям, в ОАК- анемия, резкое снижение уровня
эритроцитов, гемоглобина, тромбоцитов, могут
присутствовать патологические бластные клетки.
39.
Диагностика и лечение кишечных инфекцийОСЛОЖНЕНИЯ.
Специфические осложнения:
Кишечные кровотечения — обычно на 3-й неделе болезни; объем кровотечений от капиллярных до профузных.
Незначительные кровотечения не отражаются на состоянии больного, выявляются при осмотре стула (сгустки,
прожилки крови) или с помощью реакции Грегерсена. Мелена (черный стул) характерна для более обширных
кровотечений, при профузных кровотечениях отмечается резкое снижение температуры до нормальной или
субнормальной, тахикардия, падение АД вплоть до коллапса, может развиться геморрагический шок;
перфоративный перитонит — следствие прободения кишечной язвы, обычно на 2-3-й неделе болезни.
Перфорация может протекать бессимптомно, любые жалобы на боль в животе должны настораживать. Симптомы
развивающегося перитонита: защитное напряжение мышц брюшного пресса, положительный симптом Щеткина —
Блюмберга (не всегда), частый пульс слабого наполнения, холодный пот, коллаптоидное состояние. Спустя
несколько часов возникают рвота, упорная икота, вздутие и разлитая болезненность при пальпации живота,
исчезновение печеночной тупости. Прогноз неблагоприятный.
Инфекционно-токсический шок (ИТШ) возникает в период разгара болезни. Симптомы: резкое снижение
температуры, повышенное потоотделение, тахикардия, резкое падение АД, острая дыхательная недостаточность
(«шоковое легкое»), цианоз, олигурия, в дальнейшем — анурия.
Неспецифические осложнения вызваны наслоением вторичной флоры: пневмонии, менингиты, пиелиты,
паротиты, стоматиты и др.
40.
Диагностика и лечение кишечных инфекций.ИСХОД
При неосложненном течении прогноз благоприятный. При развитии осложнений
чаще неблагоприятный (особенно при перфоративном перитоните) летальность
составляет 0,1-0,3%
41.
Диагностика и лечение кишечных инфекций.МЕТОДЫ ЛАБОРАТОРНОГО ИССЛЕДОВАНИЯ
Основные методы диагностики — бактериологическое исследование испражнений, крови, мочи,
рвотных масс и промывных вод желудка, а также выявление антител к сальмонеллам в РНГА,
реакции Vi-агглютинации с типовыми сыворотками и/или линейной РА (реакция Видаля).
Исследования рекомендуют начинать с 7-х суток (время нарастания титра антител).
Лабораторная диагностика:
Общий анализ крови (ОАК): в первые 2-3 дня умеренный лейкоцитоз, затем лейкопения со
сдвигом формулы влево, эозинофилия, относительный лимфоцитоз, тромбоцитопения, скорость
оседания эритроцитов (СОЭ) умеренно увеличена.
Общий анализ мочи (ОАМ): протеинурия, микрогематурия, цилиндрурия.
42.
Диагностика и лечение кишечных инфекций.ПРИНЦИПЫ НЕМЕДИКАМЕНТОЗНОГО И МЕДИКАМЕНТОЗНОГО
ЛЕЧЕНИЯ.
• Режим: постельный до 10-го дня нормальной температуры. Диета: механически и
химически щадящая, калорийность достаточная, питание дробное каждые 3-4 ч; объем
вводимой жидкости 1,5-2,5 л/сут.
Этиотропная терапия:
левомицетин 2 г/сут. перорально
ампициллин 1,0 г 4-6 раз в сутки в/м.
Антибиотики используют в течение лихорадочного
периода и в первые 10 дней нормальной температуры.
Патогенетическая терапия:
глюкоза 5%, гемодез, реополиглюкин в/в (дезинтоксикация); средства, повышающие
неспецифическую резистентность организма — витамин Е, аскорбиновая кислота,
пентоксил, тимоген; нестероидные анаболики.
• Симптоматическая терапия
43.
Диагностика и лечение кишечных инфекций.ОЦЕНКА ЭФФЕКТИВНОСТИ И БЕЗОПАСТНОСТИ ПРОВОДИМОГО
ЛЕЧЕНИЯ
Индикаторы эффективности лечения:
• купирование симптомов заболевания;
• купирование осложнений (при их наличии)
44.
Диагностика и лечение кишечных инфекций.ТАКТИКА ВЕДЕНИЯ ПАЦИЕНТОВ
• Тактика ведения пациентов такая же, как и при брюшном тифе!
45.
Диагностика и лечение кишечных инфекций.ПОКАЗАНИЯ К ОКАЗАНИЮ СПЕЦИАЛИЗИРОВАННОЙ
МЕДИЦИНСКОЙ ПОМОЩИ В СТАЦИОНАРНЫХ УСЛОВИЯХ
К оказанию специализированной медицинской помощи в стационарных условиях
подлежат все пациенты имеющие наличие характерного эпидемиологического
анамнеза и клинических симптомов паратифа А и В.
100% госпитализация!
46.
Диагностика и лечение кишечных инфекций.Пищевые токсикоинфекции (ПТИ) – острые инфекционные заболевания,
вызываемые условно-патогенными бактериями, продуцирующими экзотоксины.
При попадании микроорганизмов в пищевые продукты в них накапливаются
токсины, которые могут вызывать отравления человека.
А05 – Другие бактериальные пищевые отравления.
47.
Диагностика и лечение кишечных инфекций.Возбудители ПТИ широко распространены в природе и встречаются всюду: в испражнениях
животных и людей, в почве, воде, воздухе, на различных предметах.
Источник инфекции – различные животные и люди
Все они выделяют возбудитель (обычно стафилококки), попадающие в пищевые продукты в
процессе их обработки, где и происходит размножение и накопление бактерий.
Механизм передачи – фекально-оральный, путь передачи – только пищевой.
Для возникновения ПТИ, вызываемых условно-патогенными бактериями, необходима массивная
доза возбудителей либо определенное время для его размножения в пищевых продуктах. Чаще
всего ПТИ связаны с контаминацией молока, молочных продуктов, рыбных консервов в масле,
мясных, рыбных и овощных блюд, а также кондитерских изделиях, содержащих крем.
48.
Диагностика и лечение кишечных инфекций.ЭТИОЛОГИЯ
Пищевая токсикоинфекция (ПТИ) вызывает большая группа бактерий, основные
возбудители :
Staphylococcus aureus, Proteus vulgaris, Bacillus cereus, Clostridium perfringens,
Clostridium difficile, представители родов Klebsiella, Enterobacter, Citrobacter, Serratia,
Enterococcus и др.
49.
Диагностика и лечение кишечных инфекций.ПАТОГЕНЕЗ
Общее свойство для всех возбудителей ПТИ – способность вырабатывать различные типы
экзотоксинов (энтеротоксинов) и эндотоксинов
Именно благодаря действию этих токсинов отмечают определенное своеобразие в клинических
проявлениях ПТИ, обусловленных различными возбудителями.
На исключительно важную роль бактериальных токсинов в развитии ПТИ указывает и
относительно короткий инкубационный период заболевания.
В зависимости от типов токсинов они могут вызывать гиперсекрецию жидкости в просвет
кишечника, клинические проявления гастроэнтерита и системные проявления заболевания в виде
синдрома интоксикации. Токсины бактерий реализуют свое действие через выработку эндогенных
медиаторов (цАМФ, ПГ, интерлейкинов, гистамина и др.), непостредственно регулирующих
структурно-функциональные изменения органов и систем, выявляемые у больных ПТИ.
50.
Диагностика и лечение кишечных инфекций.КЛАССИФИКАЦИЯ
Клинические формы:
1.Гастритическая
2.Энтеритическая
3. Гастроэнтеритическая
4.гастроэнтероколитическая.
Формы по степени тяжести: -лёгкая, -средней тяжести, -тяжёлая.
По этиологии: бактериальная кишечная инфекция, бактериальное
пищевое отравление (стафилококковое и др.).
По осложнениям: неосложнённая и осложнённая формы.
51.
Диагностика и лечение кишечных инфекций.КЛИНИЧЕСКАЯ КАРТИНА
Инкубационный период. Составляет, как правило, несколько часов, однако в отдельных случаях он может
укорачиваться до 30 мин или, наоборот, удлиняться до 24 часов и более.
Несмотря на полиэтиологичность ПТИ, основные клинические проявления синдрома интоксикации и
водно-электролитных расстройств при этих заболеваниях сходны меду собой и мало отличимы от
таковых при сальмонеллезе.
Для заболеваний характерно острое начало с тошноты, повторной рвоты, жидкого стула энтеритного
характера от нескольких до 10 раз в сутки и более. Боли в животе и температурная реакция могут быть
незначительными, однако в части случаев наблюдают сильные схваткообразные боли в животе,
кратковременное (до суток) повышение температуры тела до 38—39°С, озноб, общую слабость,
недомогание, головную боль.
При осмотре больных отмечают бледность кожных покровов, иногда периферический цианоз,
похолодание конечностей, болезненность при пальпации в эпигастральной и пупочной областях,
изменения частоты пульса и снижение Ад. Степень выраженности клинических проявлений дегидратации
и деминерализации зависит от объёма жидкости, теряемой больными при рвоте. Течение заболевания
короткое и в большинстве случаев составляет 1—З дня.
52.
Диагностика и лечение кишечных инфекцийДИФФЕРЕНЦИАЛЬНАЯ ДИАГНОСТИКА ПТИ
ПТИ следует отличать от сальмонеллёза и других острых кишечных инфекций —
вирусных гастроэнтеритов, шигеллёзов, холеры и др., а также от хронических
заболеваний ЖКТ, хирургической и гинекологической патологий, инфаркта
миокарда. Поскольку основные патогенетические механизмы и клинические
проявления ПТИ мало отличимы от таковых при сальмонеллёзе, в клинической
практике часто ставят обобщённый диагноз ПТИ, а выделение сальмонеллёза из
этой общей группы проводят в случае его бактериологического или
серологического подтверждения.
53.
Диагностика и лечение кишечных инфекций.ОСЛОЖНЕНИЯ.
Наблюдают крайне редко; наиболее часто — гиповолемический шок,
острая сердечно-сосудистая недостаточность, сепсис и др.
54.
Диагностика и лечение кишечных инфекций.ИСХОД
Прогноз обычно благоприятный. Смертельные исходы наблюдаются редко и
обусловлены такими осложнениями, как гиповолемический шок, острая сердечная
недостаточность, некротический энтерит, анаэробный сепсис.
55.
Диагностика и лечение кишечных инфекций.МЕТОДЫ ЛАБОРАТОРНОГО ИССЛЕДОВАНИЯ
Наибольшее значение в диагностике ПТИ имеют указанные ниже клиникоэпидемиологические данные:
1) острое начало и доминирование в клинической картине симптомов гастрита (или
гастроэнтерита);
2) отсутствие гипертермии или её кратковременность;
3) короткий инкубационный период и непродолжительность заболевания;
4) групповой характер заболеваемости и связь болезни с употреблением одного и
того же пищевого продукта;
56.
Диагностика и лечение кишечных инфекций.МЕТОДЫ ЛАБОРАТОРНОГО ИССЛЕДОВАНИЯ
Основу составляет выделение возбудителя из рвотных масс, промывных вод и испражнений.
При высеве возбудителя необходимо изучение его токсигенных свойств. Однако в большинстве
случаев выделяемость незначительна, а обнаружение конкретного микроорганизма у больного ещё
не позволяет считать его виновником заболевания.
При этом необходимо доказать его этиологическую роль либо с помощью серологических реакций
с аутоштаммом, либо установление идентичности возбудителей, выделенных из заражённого
продукта и от лиц, употреблявших его.
Серологический метод в диагностике ПТИ самостоятельного значения не имеет, доказательным
является лишь нарастание титра антител к аутоштамму выделенного микроорганизма
57.
Диагностика и лечение кишечных инфекций.ПРИНЦИПЫ НЕМЕДИКАМЕНТОЗНОГО И МЕДИКАМЕНТОЗНОГО ЛЕЧЕНИЯ.
При установлении клинико-эпидемиологического диагноза ПТИ необходимо провести тщательное и
многократное промывание желудка (до получения чистых промывных вод).
Промывание проводят 2–4% раствором натрия гидрокарбоната. При выраженной диарее назначается
активированный уголь или другие адсорбенты (полифепан, карбонат кальция). При отсутствии стула
делают встречную высокую клизму (типа сифонной). Дальнейшее лечение проводится с учётом степени
дегидратации у больного.
Назначение антибиотиков, сульфаниламидов и других химиопрепаратов при не осложненном течении ПТИ
нецелесообразно.
Во время болезни и в период реконвалесценции показаны лечебное питание, ферментные препараты
(фестал, панзинорм и др.), витамины.
58.
Диагностика и лечение кишечных инфекций.ОЦЕНКА ЭФФЕКТИВНОСТИ И БЕЗОПАСТНОСТИ
ПРОВОДИМОГО ЛЕЧЕНИЯ
Индикаторы эффективности лечения:
• купирование симптомов заболевания;
• купирование осложнений (при их наличии)
59.
Диагностика и лечение кишечных инфекцийПОКАЗАНИЯ К ОКАЗАНИЮ СПЕЦИАЛИЗИРОВАННОЙ
МЕДИЦИНСКОЙ ПОМОЩИ В СТАЦИОНАРНЫХ УСЛОВИЯХ
При тяжелом течении заболевания, пациенту будет оказана помощь в
стационарных условиях.
60.
Диагностика и лечение кишечных инфекций.Ботулизм – острая инфекционная болезнь из группы
сапрозоонозов преимущественно с фекально-оральным
механизмом передачи, развивающаяся в результате употребления
пищевых продуктов, в которых произошло накопление токсина
возбудителя, блокирующего передачу нервных импульсов
Ботулизм - острое заболевание инфекционно-токсического
генеза,
обусловленное действием нейротоксина, вырабатываемого веге
тативными формами возбудителя
Clostridium bоtulinum (Cl.bоtulinum) и клинически характеризу
ющееся парезами и параличами поперечнополосатой и гладкой
мускулатуры, иногда в сочетании с синдромом гастроэнтерита в
начальном периоде
А05.1 - Ботулизм
61.
Диагностика и лечение кишечных инфекций.ЭТИОЛОГИЯ
Сl.bоtulinum (отдел Firmicutes род Clostridium) – грамположительный
спорообразующий анаэроб, патогенность которого обусловлена
способностью выделять экзотоксин (ботулинический токсин), оказывающий
нейротоксичное действие. Оптимальная температура роста и
токсинообразования Сl.bоtulinum +28÷35°С, рН среды 7,2-7,4. В
неблагоприятных условиях кислородсодержащей атмосферы Сl.bоtulinum
трансформируется в спору, по внешнему виду при микроскопии
напоминающую теннисную ракетку. Споры бактерий Сl.bоtulinum типа А
способны сохранять жизнеспособность в течение 6-8 лет в пресной воде, 2-х
месяцев в соленой воде, выдерживают солнечный свет и глубокое
замораживание, способны к воспроизводству после высушивания в течение
347 дней и более чем столетнего пребывания в почве. Жизнеспособные
споры встречаются в овощах и фруктах, в личинках мух и дождевых червей,
колонизируют желудочно-кишечный тракт рыб, птиц, и млекопитающих.
Уничтожение спор может быть достигнуто путем кипячения в воде (в течение
6 ч при температуре 100° С или 20 мин при температуре 120° С), не менее
чем 24-часовой обработкой 20% формалином или нагреванием в течение 1 ч в
10% соляной кислоте. В благоприятных условиях споры за 30-40 мин
прорастают в вегетативную бактериальную форму, способную к
размножению. Размножение бактерий возможно только в анаэробных
условиях.
62.
Диагностика и лечение кишечных инфекций.ЭТИОЛОГИЯ
В качестве источника ботулотоксина на первом месте в
нашей стране находятся консервированные домашним
способом грибы (60–65 % случаев), овощи и несколько
реже соленая и копченая рыба кустарного производства.
Опасности домашнего консервирования очевидны:
термостойкость спор позволяет им переносить даже
длительное кипячение при 100–110°С, концентрации солей
и уксуса, применяемые при консервировании, не
препятствуют токсинообразованию, а герметизация банок с
самодельными консервами приводят к созданию
анаэробных условий. Возможно накопление БнТ в
продуктах в вакуумной упаковке.
63.
Диагностика и лечение кишечных инфекций.ПАТОГЕНЕЗ
Начальным звеном патогенеза пищевого ботулизма является всасывание токсина из верхних отделов ЖКТ в
кровь с дальнейшим проникновением его через гематоэнцефалический барьер в ЦНС. Ботулинический токсин
избирательно поражает холинергические структуры различных отделов нервной системы: мотонейроны
передних рогов спинного мозга и нервные окончания. Механизм действия ботулинического токсина
реализуется за счет блокирования передачи импульса от нервного окончания к мышце, посредством
блокировки выброса нервным окончанием нейромедиатора ацетилхолина.
Условно действие ботулинического токсина разделяется на три стадии:
- первая стадия действия ботулинического токсина заключается в специфическом связывании молекулы с
пресинаптической мембраной;
- вторая стадия – в проникновении связанного токсина в цитоплазму нейронов путем эндоцитоза. Внутри
клетки легкая цепь проявляет Zn2+-зависимую протеазную активность, избирательно разрушая фермент
SNAP-25;
- третья стадия – в блокаде высвобождения ацетилхолина из пресинаптических окончаний холинергических
нейронов.
64.
Диагностика и лечение кишечных инфекций.КЛАССИФИКАЦИЯ
По классификации ВОЗ:
Пищевой ботулизм - заболевание развивается в результате употребления в пищу продуктов, накопивших ботулинический токсин;
Раневой ботулизм – развивается при загрязнении почвой раны, в которой создаются условия для прорастания и последующего
токсинообразования попавших из почвы Cl. botulinum;
Ботулизм детского возраста – возникает у детей преимущественно до 6
месяцев при инфицировании их Cl. botulinum;
Ботулизм неуточнённой природы – установить связь между заболеванием и
пищевым продуктом не удается.
По степени тяжести:
легкая форма ботулизма - характеризуется малой выраженностью всей симптоматики;
среднетяжелая форма ботулизма - случаи заболевания с выраженными неврологическими проявлениями без признаков
декомпенсированной острой дыхательной недостаточности, с полностью сохраненной способностью к глотанию.
тяжелая форма ботулизма – характеризуется максимальной выраженностью всех симптомов заболевания с признаками
декомпенсированной острой дыхательной недостаточности, нарушением глотания жидкости любой степени выраженности.
65.
Диагностика и лечение кишечных инфекций.КЛИНИЧЕСКАЯ КАРТИНА
Начальный период
По характеру основных клинических проявлений ботулизма в начальный период условно можно выделить
следующие варианты.
При гастроэнтеритическом варианте:
возникают боли в эпигастральной области схваткообразного характера, возможны однократная или повторная рвота
съеденной пищей, боли в животе, послабление стула. Заболевание напоминает проявления пищевых
токсикоинфекций.
Вместе с этим следует учитывать, что при ботулизме диспепсические признаки кратковременны и исчезают к
моменту появления неврологической симптоматики, в начальном периоде не бывает выраженного повышения
температуры тела. Развивается сильная сухость слизистых оболочек ротовой полости, которую нельзя объяснить
незначительной потерей жидкости, она связана с атропиноподобным действием ботулотоксина. Частым симптомом в
начальном периоде бывает затруднение прохождения пищи по пищеводу (комок в горле).
Глазной (офталъмоплегический) вариант проявляется расстройствами зрения — появлением тумана, сетки, мушек
перед глазами, теряется четкость контуров предметов, возникает их двоение (диплопия). В некоторых случаях
развивается острая дальнозоркость, корригируемая плюсовыми линзами.
66.
Диагностика и лечение кишечных инфекций.КЛИНИЧЕСКАЯ КАРТИНА
Период разгара
Клинические проявления ботулизма достаточно характерны и отличаются сочетанием ряда синдромов,
связанных с поражением ядер различных черепных нервов.
При развитии офталъмоплегического синдрома сохраняются и усиливаются расстройства зрения,
описанные в начальном периоде болезни. Можно наблюдать двусторонний блефароптоз, стойкий мидриаз,
анизокарию, снижение реакции зрачков на свет, нарушения движения глазных яблок (чаще сходящийся
стробизм), вертикальный нистагм, синдром нарушения глотания, выражающийся в затруднении
проглатывания сначала твердой, а затем и жидкой пищи (при попытке выпить воду она выливается у
больного через нос), гнусавостью голоса, дизартрией,.
У больного отсутствует кашлевой толчок, что приводит к приступу удушья при попадании слизи или жидкости в
гортань. В ряде случаев, но не постоянно выявляют нарушения иннервации со стороны лицевого нерва мышц
мимической мускулатуры, сильнейшая мышечная слабость; походка становится неустойчивой (пьяная походка).
С первых часов заболевания типична выраженная сухость слизистых оболочек полости рта. Развиваются
запоры, связанные с парезом кишечника. Температура тела остается нормальной и лишь изредка повышается до
субфебрильных цифр. Характерна тахикардия, в некоторых случаях отмечают небольшую артериальную
гипертензию.
Сознание и слух полностью сохранены. Характерно отсутствие нарушений со стороны чувствительной сферы.
Расстройства дыхания обусловлены поражением мотонейронов передних рогов шейного и верхнегрудного
отделов спинного мозга с угнетением иннервации диафрагмальных и межреберных мышц.
Период реконвалесценции при ботулизме продолжительный, иногда затягивается на несколько месяцев.
67.
Диагностика и лечение кишечных инфекций.ДИФФЕРЕНЦИАЛЬНАЯ ДИАГНОСТИКА БОТУЛИЗМА
- с ПТИ - в начальном периоде при синдроме острого гастроэнтерита;
- с миастеническим синдромом - при парезах или параличах;
- с дифтерийными полиневритами - при поражении черепных нервов,
периферической нервной системы;
- с вирусными энцефалитами - при наличии очаговой симптоматики;
- с ОНМК – при наличии диплопии, дисфонии, дисфагии, дизартрии;
- с синдромом Гийена-Барре - при наличии офтальмоплегии, арефлексии,
атаксии
68.
Диагностика и лечение кишечных инфекций.ОСЛОЖНЕНИЯ.
Единственным специфическим осложнением ботулизма можно считать поражения
сердца в виде миокардиодистрофии («ботулинический миокардит»).
Миокардиодистрофия возникает, как правило, на 7 - 15-й день болезни. На ЭКГ
проявляет себя замедлением внутрижелудочковой проводимости и, по данным УЗИ,
сопровождается резким снижением фракции выброса. К неспецифическим
осложнениям относятся бактериальные вторичные осложнения, среди которых чаще
наблюдается пневмония.
69.
Диагностика и лечение кишечных инфекций.ИСХОД
Прогноз при высокой дозе полученного токсина и отсутствии своевременной
медицинской помощи может быть крайне неблагоприятным, летальность таких
случаев достигает 30-60%. Применение этиотропного лечения и методов
интенсивной терапии при развитии грозных осложнений значительно снижают риск
летального исхода (до 3-4%). В случае своевременного лечения заболевание
заканчивается выздоровлением с полным восстановлением функций через
несколько месяцев.
70.
Диагностика и лечение кишечных инфекций.МЕТОДЫ ЛАБОРАТОРНОГО И ИНСТРУМЕНТАЛЬНОГО ИССЛЕДОВАНИЯ
Лабораторные исследования:
1.Обнаружение ботулинического токсина в крови методом реакции нейтрализации ботулотоксинов антитоксическими
сыворотками с биопробой на белых мышах служит абсолютным подтверждением диагноза;
2.выделение возбудителя ботулизма из содержимого желудка (рвотные массы и промывные воды), испражнений,
подозрительных продуктов путем бак. посева на специальные питательные среды (Китта–Тароцци, казеиново-грибную,
Тиогликолевая среда, бульон Хоттингера и др.)
3. ПЦР - Масс-спектрометрический метод обнаружения ботулинического нейротоксина (Эндоцеп-МС) является
высокочувствительным и специфичным и позволяет дифференцировать ботулиническй нейротоксин серотипов А,В,Е, и F в
течение нескольких часов
4. ОАК - Умеренный лейкоцитоз с нейтрофилезом, повышение СОЭ
5. ОАМ- Снижение относительной плотности, незначительная лейкоцитурия, микрогематурия, цилиндрурия
6. Биохимический анализ крови - при среднетяжёлом и тяжёлом течении - повышение активности
«кардиоспецифических» энзимов (КФК-МВ, АсТ и ЛДГ-1,2), уровня тропонина.
Инструментальные исследования:
1. УЗИ органов брюшной полости
2. ЭКГ
3. Рентген органов грудной клетки
71.
Диагностика и лечение кишечных инфекций.ПРИНЦИПЫ НЕМЕДИКАМЕНТОЗНОГО И МЕДИКАМЕНТОЗНОГО ЛЕЧЕНИЯ.
Немедикаментозное лечение:
режим постельный или полупостельный
диета: стол №10, зондовое или парентеральное питание в зависимости от состояния больного
введение назогастрального зонда для эвакуации застойного содержимого и фракционного промывания
желудка 5% раствором натрия гидрокарбоната с целью инактивации токсина 1-2 раза в сутки в течение 34 дней до полной ликвидации застоя;
очищение кишечника с помощью сифонных клизм;
энтеральное питание через назогастральный зонд, инфузией в течение 16 ч. питательными смесями с
высокой энергетической плотностью. Объём белка в сутки из расчёта 25 ккал/кг массы тела и 1,5 г/кг
массы тела
72.
Диагностика и лечение кишечных инфекций.ПРИНЦИПЫ НЕМЕДИКАМЕНТОЗНОГО И МЕДИКАМЕНТОЗНОГО
ЛЕЧЕНИЯ.
Медикаментозное лечение:
Важнейшие первоначальные решения о лечении и
ведении пациентов с подозрением на ботулизм
должны приниматься на основе клинических данных.
Ботулинический антитоксин, единственный
специфический препарат для лечения ботулизма,
должен быть введен как можно быстрее.
Поскольку лабораторное подтверждение может занять
несколько дней, отсрочка введения антитоксина
пациенту с высокой или средней вероятностью
ботулизма в ожидании лабораторных результатов
может ухудшить исход пациента
73.
Диагностика и лечение кишечных инфекций.Организация оказания медицинской помощи пациентам с инфекционными заболеваниями.
Роль фельдшера в ранней диагностике инфекционных заболеваний.
ПРИНЦИПЫ НЕМЕДИКАМЕНТОЗНОГО И МЕДИКАМЕНТОЗНОГО ЛЕЧЕНИЯ.
Другие виды лечения, оказываемые на амбулаторном уровне:
• промывание желудка кипяченой водой с целью нейтрализации токсина.
Другие виды лечения, оказываемые на стационарном уровне:
• гипербарическая оксигенация.
В случаях раневого ботулизма – соответствующая хирургическая обработка раны, применяют повышенные
дозы (до 12–16 млн. ЕД/сут) пенициллина.
Другие виды лечения, оказываемые на этапе скорой неотложной помощи:
• промывание желудка вначале кипяченой водой для получения материала для лабораторного исследования,
а затем 2–5%-ным раствором натрия гидрокарбоната с целью нейтрализации токсина.
74.
Диагностика и лечение кишечных инфекций.Организация оказания медицинской помощи пациентам с инфекционными заболеваниями.
Роль фельдшера в ранней диагностике инфекционных заболеваний.
ОЦЕНКА ЭФФЕКТИВНОСТИ И БЕЗОПАСТНОСТИ ПРОВОДИМОГО
ЛЕЧЕНИЯ
Индикаторы эффективности лечения:
• купирование симптомов заболевания;
• купирование осложнений (при их наличии)
75.
Диагностика и лечение кишечных инфекций.ТАКТИКА ВЕДЕНИЯ ПАЦИЕНТОВ
В зависимости от выявленных осложнений пациент наблюдается врачамиспециалистами (невролог, кардиолог, пульмонолог и др). Специальных
программ реабилитации для больных, перенесших ботулизм нет.
Реабилитационные мероприятия назначают врачи-специалисты
соответствующего профиля.
Диспансерное наблюдение за переболевшими не регламентировано.
Рекомендовано наблюдение не менее 6 месяцев при развитии поражений и
сохранении симптоматики с нарушением зрения, глотания, афонией,
нарушением сердечного ритма и др. с участием врачей соответствующей
специальности (невролога, кардиолога, офтальмолога).
76.
Диагностика и лечение кишечных инфекций.ПОКАЗАНИЯ К ОКАЗАНИЮ СПЕЦИАЛИЗИРОВАННОЙ
МЕДИЦИНСКОЙ ПОМОЩИ В СТАЦИОНАРНЫХ УСЛОВИЯХ
При подозрении на ботулизм показана экстренная госпитализация в инфекционный стационар,
инфекционное отделение при многопрофильной клинике.
При тяжелой форме в отделение интенсивной терапии или реанимации.
77.
Диагностика и лечение кишечных инфекций.Сальмонеллез - острое инфекционное зооантропонозное заболевание с фекальнооральным
механизмом передачи, вызываемое Salmonella spp., характеризующееся разнообразными
клиническими проявлениями от бессимптомного носительства до развития в редких случаях
генерализованных форм (тифоподобной, септицемической и септикопиемической). В большинстве
случаев протекает с преимущественным поражением органов пищеварительного тракта
(гастроэнтериты, колиты)
А02 - Другие сальмонеллезные инфекции:
А02.0 - Сальмонеллезный энтерит
А02.1 - Сальмонеллезная септицемия
А02.2 - Локализованная сальмонеллезная инфекция
А02.8 - Другая уточненная сальмонеллезная инфекция
А02.9 - Сальмонеллезная инфекция неуточненная
78.
Диагностика и лечение кишечных инфекций.Организация оказания медицинской помощи пациентам с инфекционными заболеваниями.
Роль фельдшера в ранней диагностике инфекционных заболеваний.
Заболеваемость сальмонеллезом носит спорадический характер, но также регистрируются
крупные пищевые, реже водные вспышки, очаги нозокомиальной инфекции (родильные
дома, реанимационные отделения, отделения для детей раннего возраста) и вспышки в
закрытых учреждениях (дома престарелых, психоневрологические интернаты).Наиболее
высокая заболеваемость сальмонеллезом характерна для детей раннего и дошкольного
возраста.
Источником инфекции при сальмонеллезе являются животные и человек (больные и
бактерионосители.
Основной путь распространения инфекции - пищевой, причем ведущим фактором
передачи является инфицированные продукты птицеводства: мясо кур, индеек,
водоплавающих птиц и яйца, меньшую эпидемиологическую значимость имеют свинина,
говядина.
79.
Диагностика и лечение кишечных инфекций.ЭТИОЛОГИЯ
Возбудители сальмонеллеза относятся к семейству Еnterobacteriaceae роду Salmonella, который включает 2 вида (на
основании строения ДНК): Salmonella еntericса с пятью подвидами (в каждом из которых множество серотипов в
зависимости от наличия О- и Н-антигенов) и Salmonella bongori (включает менее 10 очень редких сероваров),
причем последний для человека не патогенен.
Сальмонеллы - грамотрицательные палочки 0,7-1,5x2-5 мкм, имеют от 8 до 20 жгутиков, подвижны, спор не
образуют, факультативные анаэробы, хорошо растут на питательных средах при температуре от +6 до +46° С
(оптимум роста +37° С, при рН составляет 7,2-7,4).
Сальмонеллы длительно сохраняются в окружающей среде, низкую температуру переносят в течение нескольких
месяцев. При 60°С сальмонеллы погибают через 20-30 минут, при 100°С - мгновенно. На белье бактерии могут
сохраняться 14-80 дней, в испражнениях до 30 дней, в высушенных фекалиях - до 4-х лет. В проточной воде
выживают до 10 дней, водопроводной - до 4-5 месяцев, в пыли - до 6 месяцев. В пищевых продуктах сальмонеллы
не только хорошо сохраняются: в замороженном мясе — до 3-6 мес., в замороженных тушках птиц — до 1 года, в
колбасах, сосисках — до 2-3 мес., в сливочном масле, сыре, яичном порошке — 9-12 мес., но и размножаются.
Сальмонеллы отличает способность быстро вырабатывать резистентность ко многим противомикробным
препаратам.
80.
Диагностика и лечение кишечных инфекцийЭТИОЛОГИЯ
Salmonella еntericса
81.
Диагностика и лечение кишечных инфекцийПАТОГЕНЕЗ
Основным местом развития патологического процесса при сальмонеллезе является желудочнокишечный тракт, чаще тонкий кишечник, реже поражение толстого кишечника, при
генерализованной форме характерно поражение других органов и систем (печень, селезенка,
легкие, лимфатические узлы, кости). При хронических формах сальмонеллеза на фоне первичного
иммунодефицита при гистологическом исследовании паренхиматозных органов выявляют
гиперплазию лимфоидной ткани, очаговый склероз и признаки хронического воспаления без черт
специфичности.
За счет имеющихся жгутиков сальмонеллы преодолевают слой слизи и быстро прикрепляются к
энтероцитам. Они обеспечивают быстрое преодоление слизистого барьера, устойчивость к
бактерицидному действию катионных белков и колонизации слизистой. Факторы инвазии
определяют способность возбудителя к инвазии. Сальмонеллы проникают в слизистую оболочку
кишечника через М-клетки слизистой, в результате инвазии М-клетки погибают, а бактерии
инвазируются в собственную пластинку и лимфоидные образования кишечника, далее
сальмонеллы проникают в брыжеечные лимфоузлы, грудной лимфатический проток и попадают
кровоток. Факторы патогенности обуславливают проникновение, выживание в цитоплазме
фагоцитов и способность инициировать их апоптоз. В результате фагоцитоз приобретает
незавершенный характер, что может явиться фактором генерализации инфекции.
82.
Диагностика и лечение кишечных инфекцийКЛАССИФИКАЦИЯ
Гастроинтестинальная форма
- гастритический вариант
- гастроэнтеритический вариант
- гастроэнтероколитический вариант
Генерализованная форма
- тифоподобный вариант
- септикопиемический вариант
Бактериовыделение
- острое
- хронической
- транзиторное
83.
Диагностика и лечение кишечных инфекцийКЛИНИЧЕСКАЯ КАРТИНА
Инкубационный период длится от 6 ч до 3 суток (чаще 12-24 ч).
Для гастритического варианта характерны острое начало, повторная рвота и боль в эпигастрии. Синдром
интоксикации выражен слабо. Обычно заболевание продолжается 2-3 дня.
Наиболее распространен гастроэнтеритическаий вариант заболевания. Заболевание начинается остро, с
симптомов интоксикации: повышения температуры тела до высоких цифр с первых часов заболевания 38,5-39,5°С,
головной боли, озноба, схваткообразной боли в животе. Присоединяется тошнота, рвота, как правило
предшествующие диарее. Испражнения вначале носят каловый характер, но быстро становятся обильными,
водянистыми, пенистыми, зловонными, иногда с зеленоватым оттенком, имеющим вид «болотной тины», иногда с
примесью слизи. Тенезмы и ложные позывы отсутствуют. Отмечаются бледность кожных покровов. Язык сухой,
обложен налетом. Живот вздут, при пальпации болезнен во всех отделах, больше в эпигастрии и правой подвздошной
области, урчит под рукой. Тоны сердца приглушены, тахикардия, артериальное давление снижено. Уменьшение
выделения мочи. Возможны судороги.
84.
Диагностика и лечение кишечных инфекцийКЛИНИЧЕСКАЯ КАРТИНА
При гастоэнтероколитическом варианте клиническая картина та же, но уже на 2-3 день уменьшается объем
испражнений. В них появляется примесь слизи, иногда и крови. При пальпации отмечаются спазм и болезненность
сигмовидной кишки. Возможны тенезмы.
При тифоподобном варианте температурная кривая принимает постоянный или волнообразный характер.
Наблюдаются выраженная головная боль, бессоница, головокружение. Кожные покровы бледные на 5-7 дней может
появится розеолезная сыпь. Над легкими могут выслушиваться рассеянные сухие хрипы. При исследовании
сердечнососудистой системы наблюдаются приглушенность сердечных тонов, тахикардия, редко брадикардия. Живот
вздут. К 5-7 дню наблюдаются гепатомегалия и спленомегалия. Со стороны почек - олигоурия.
При генерализованном септикопиемическом варианте сальмонеллеза начальные проявления схожи с тифоподобным,
в дальнейшем состояние пациента ухудшается. Колебания температуры становятся неправильными с большими
суточными колебаниями, повторным ознобом и обильным потоотделением, тахикардией, миалгией.
Отмечается формирование гнойных очагов в легких, сердце, почках, печени и других органах. Болезнь протекает
длительно и может закончится летально
85.
Диагностика и лечение кишечных инфекцийДИФФЕРЕНЦИАЛЬНАЯ
ДИАГНОСТИКА
САЛЬМОНЕЛЛЕЗА
86.
Диагностика и лечение кишечных инфекцийОСЛОЖНЕНИЯ.
1. Специфические
2. Неспецифические
Токсико-инфекционный шок
Нарушение кровообращения в сосудах (коронарный,
мезентериальные, мозговые)
Дегидратационный шок
Острая почечная недостаточность
Абсцесс
Инфекционный психоз
Инфекционно-токсическая энцефалопатия
Анемия
Панкреатит
Менингит
Миокардит
Пневмония
Тромбофлебит
Холецистит
Остеомиелит и др
87.
Диагностика и лечение кишечных инфекцийИСХОД
Отрицательно влияют на исход заболевания:
1. Позднее обращение и позднее поступление в стационар;
2. Наличие специфических осложнений: ТИШ, ДВС-синдром, дегидратационный
шок;
3. Наличие сопутствующих заболеваний, отягощающих течение сальмонеллеза
(ВИЧ-инфекция, онкопатология и др.).
88.
Диагностика и лечение кишечных инфекцийМЕТОДЫ ЛАБОРАТОРНОГО И ИНСТРУМЕНТАЛЬНОГО
ИССЛЕДОВАНИЯ
Лабораторные исследования:
1. Бактериологический метод
2. Серологический метод
3. ПЦР (кала)
4. ОАК - лейкоцитоз
5. ОАМ – могут быть эритроциты в моче
6. Биохимический анализ крови
Инструментальные исследования:
1. УЗИ органов брюшной полости
89.
Диагностика и лечение кишечных инфекцийОЦЕНКА ЭФФЕКТИВНОСТИ И БЕЗОПАСТНОСТИ ПРОВОДИМОГО
ЛЕЧЕНИЯ
Индикаторы эффективности лечения:
• купирование симптомов заболевания;
• купирование осложнений (при их наличии)
90.
Диагностика и лечение кишечных инфекцийПРИНЦИПЫ НЕМЕДИКАМЕНТОЗНОГО И МЕДИКАМЕНТОЗНОГО
ЛЕЧЕНИЯ.
Немедикаментозное лечение:
1. Щадящая диета.
Разрешаются: протертые вегетарианские или на нежирном мясном бульоне крупяные супы или первые
блюда с мелконарезанными или протертыми овощами,различные мясные блюда из нежирных сортов мяса;
отварные блюда из нежирной рыбы, сыр твердых сортов; подсушенный белый хлеб, сухари, сушки,
несдобное печенье. Яблоки разрешаются печеные, в протертом виде.
Следует подчеркнуть, что диета назначается в острый период сальмонеллеза при выраженных общих
инфекционных и местных симптомах (2-4 дня)
91.
Диагностика и лечение кишечных инфекцийПРИНЦИПЫ НЕМЕДИКАМЕНТОЗНОГО И МЕДИКАМЕНТОЗНОГО ЛЕЧЕНИЯ.
Медикаментозное лечение:
1.1 Этиотропная терапия:
Цель терапии:
- Воздействие на Salmonella spp. с целью снижения их
патологического влияния на организм;
- снижение тяжести течения заболевания;
- уменьшение риска развития специфических
осложнений.
препаратами выбора являются фторхинолоны!
92.
Диагностика и лечение кишечных инфекцийПРИНЦИПЫ НЕМЕДИКАМЕНТОЗНОГО И МЕДИКАМЕНТОЗНОГО ЛЕЧЕНИЯ.
1.2. Патогенетическая терапия
Цель патогенетической терапии:
Рекомендована регидратация, включая оральную регидратацию и
инфузионную терапию:
принципами оральной регидратации является дробность введение
жидкости, применение растворов с оптимальным составом
(регидратационные растворы со сниженной осмолярность 200—
- уменьшение интоксикации;
240 мосмоль/л). Оральная регидратация проводится в два этапа:
- профилактика специфических осложнений (ТИШ, ОПН, отек
I этап — в первые 6 часов после поступления пациента
легких, отек мозга, ДВС-синдром);
ликвидируют водно-солевой дефицит, возникающий до начала
лечения. II этап - поддерживающая оральная регидратация,
- коррекция нарушений водно-электролитного баланса
которую проводят весь последующий период болезни при наличии
- нормализация функционирования эюелудочно-кишечного тракта; продолжающихся потерь жидкости и электролитов.
Эффективность оральной регидратации оценивается по
- восстановление нормальной микрофлоры кишечника.
следующим признакам: уменьшению объема потерь эюидкости;
Объем и интенсивность терапии определяется формой, степенью сниэ/сению скорости потери массы тела; исчезновению
клинических признаков обезвоживания; нормализации диуреза;
тяжести заболевания, наличия осложнений.
улучшению общего состояния.
- возмещение объема циркулирующей крови;
К парентеральной регидратации прибегают при отсутствии
эффекта от оральной регидратации, при развитии дегидратации II
и II-III степени, при дегидратации 1-II степени в сочетании с
симптомами интоксикации, при развитии неотлоэтых состояний
(ТИШ, дегидратационный шок, ОПН и др.).
93.
Диагностика и лечение кишечных инфекцийТАКТИКА ВЕДЕНИЯ ПАЦИЕНТОВ
Госпитализация пациентов со средне - тяжелыми, тяжелыми и осложненными
формами заболевания, по эпидемиологическим показаниям.
Амбулаторное лечение пациентов с легкой формой заболевания при отсутствии
эпидемиологических, социальных показаний для госпитализации.
94.
Диагностика и лечение кишечных инфекцийПОКАЗАНИЯ К ОКАЗАНИЮ СПЕЦИАЛИЗИРОВАННОЙ МЕДИЦИНСКОЙ
ПОМОЩИ В СТАЦИОНАРНЫХ УСЛОВИЯХ
Рекомендована госпитализация в инфекционное отделение пациентам с сальмонеллезом в случаи:
- тяжелого течения;
- обезвоживания Ш-1У степени;
- генерализации осложнений;
- эпидемиологических показаний.
95.
Диагностика и лечение кишечных инфекцийШигеллёз — острая инфекционная болезнь,
вызываемая бактериями рода Shigella с фекальнооральным механизмом передачи возбудителя и
характеризующаяся картиной дистального колита и
интоксикацией
А03.9 – Шигеллез неуточненный
96.
Диагностика и лечение кишечных инфекцийЕдинственный источник возбудителя шигеллёза — человек, больной манифестной или стёртой
формой болезни, а также бактериовыделитель. Наибольшую опасность представляют больные,
которые по роду своей работы связаны с приготовлением пищи, хранением, транспортировкой и
продажей пищевых продуктов.
Шигеллёз распространяется с помощью фекально-орального механизма передачи возбудителя.
Этот механизм включает передачу возбудителя контактно-бытовым, водным, пищевым путём.
Болезнь распространена повсеместно, но заболеваемость преобладает в развивающихся странах
среди контингента населения с неудовлетворительным социально-экономическим и санитарногигиеническим статусом.
Для стран с умеренным климатом характерна летне-осенняя сезонность.
Восприимчивость населения к шигеллёзу высока во всех возрастных группах, наиболее часто
болеют дети. После перенесённого заболевания формируется непродолжительный
типоспецифический иммунитет.
97.
Диагностика и лечение кишечных инфекцийЭТИОЛОГИЯ
Шигеллёз вызывается рядом биологически близких между собой микроорганизмов, относящихся к семейству Enterobacteriacea и
объединённых в род Shigella.
По современной классификации, род Shigella подразделяют на четыре вида:
• группа A: Shigella Dysenteriae, 1 — Григорьева-Шиги, Shigella Dysenteriae, 2 — Штутцера-Шмитца и Shigella Dysenteriae 3-7 —
Ларджа-Сакса;
• группа В: Shigella Flexneri с подвидом Shigella Flexneri 6 — Newcastle; серовары 1-6, каждый из которых подразделяют на подсеровары
а и b, а также серовары 6, X и Y;
• группа С: Shigella Boydi, серовары 1-18;
•группаD:ShigellaSonnei.
Шигеллы — грамотрицательные неподвижные палочки, факультативные аэробы. Палочка Григорьева-Шиги образует шигитоксин
(экзотоксин), остальные виды содержат термолабильный эндотоксин — ЛПС. Наименьшая заражающая доза характерна для бактерий
Григорьева-Шиги, большая — для бактерий Флекснера и наибольшая — для бактерий Зонне. Представители последних двух видов
наиболее устойчивы в окружающей среде: на посуде и влажном белье они могут сохраняться в течение месяцев, в почве — до 3 мес, на
продуктах питания — несколько суток, в воде — до 3 мес. При нагревании до 60 °С они гибнут через 10 мин, при кипячении —
немедленно, в дезинфицирующих растворах — в течение нескольких минут. Из антибактериальных препаратов наибольшая
чувствительность
in
vitro
отмечена
к
фторхинолонам
(100%).
98.
Диагностика и лечение кишечных инфекцийЭТИОЛОГИЯ
Shigella.
99.
Диагностика и лечение кишечных инфекцийПАТОГЕНЕЗ
В течение суток (иногда и дольше) шигеллы могут находиться в желудке. При этом некоторые из
них здесь же распадаются, выделяя эндотоксин. Оставшиеся бактерии попадают в тонкую кишку,
где могут задерживаться до нескольких суток и даже размножаться. Далее шигеллы продвигаются в
нижележащие отделы кишечника, где также размножаются и распадаются в большем количестве,
чем в тонкой кишке. Определяющий момент в развитии инфекционного процесса при шигеллёзе —
способность шигелл к внутриклеточной инвазии. Первостепенное значение среди защитных
механизмов имеет состояние естественных факторов резистентности, особенно местных (лизоцим
и (β-лизины слизистой оболочки дистального отдела толстой кишки). Вместе с гуморальными
факторами (бактерицидная активность, лизоцим, комплемент сыворотки крови) они реагируют
на развитие инфекционного процесса на протяжении всего заболевания.
Степень неспецифической резистентности в известной мере определена генетически, но в то же
время она зависит от ряда факторов: возраста больного, полноценности питания, сопутствующих
заболеваний.
100.
Диагностика и лечение кишечных инфекцийКЛАССИФИКАЦИЯ
Форма
Острый
шигеллёз
Клинический
вариант
Колитический
Гастроэнтероколитический
Гастроэнтеритический
Хронический
шигеллёз
Шигеллёзное
бактерионосительство
-
-
Особенности
течения
Этиология
Лёгкое;
среднетяжёлое; тяжёлое
Лёгкое; среднетяжёлое с обезвоживанием
HI степени; тяжёлое с
обезвоживанием III-IV степени
Лёгкое; среднетяжёлое с обезвоживанием
HI степени; тяжёлое с
обезвоживанием III-IV степени
Стёртое, затяжное
Шигеллы любого
из перечисленных
видов: Зонне,
Флекснера, Бойда,
Григорьева-Шиги,
Ларджа-Сакса,
Штутцера-Шмитца
-
Рецидивирующее,
непрерывное
-
Субклиническое,
реконвалесцентное
Тяжесть течения
101.
Диагностика и лечение кишечных инфекцийКЛИНИЧЕСКАЯ КАРТИНА
Инкубационный период при остром шигеллёзе в большинстве случаев ограничивается 2 - 5 сут. Продолжительность заболевания
составляет от нескольких дней до 3 мес, шигеллёз длительностью свыше 3 мес расценивают как хронический.
Клиническая картина колитического варианта острого шигеллёза
Этот вариант течения заболевания диагностируют чаще всего в клинической практике. Заболевание, как правило, начинается остро,
у некоторых больных удаётся установить кратковременный продромальный период, проявляющийся непродолжительным чувством
дискомфорта в животе, лёгким ознобом, головной болью, слабостью. После продромального периода (а чаще на фоне полного
здоровья) появляются характерные симптомы заболевания. Прежде всего возникают схваткообразные боли в нижней части живота,
преимущественно в левой подвздошной области; иногда боль имеет разлитой характер, атипичную локализацию (эпигастральная,
умбиликальная, правая подвздошная область). Особенность болевого синдрома — его уменьшение или кратковременное
исчезновение после дефекации. Позывы к дефекации появляются одновременно с болью или несколько позже. Стул первоначально
каловый, постепенно объём каловых масс уменьшается, появляется примесь слизи и крови, частота дефекаций нарастает. В разгаре
болезни испражнения могут терять каловый характер и имеют вид так называемого ректального плевка, т.е. состоят лишь из
скудного количества слизи и крови. Дефекация может сопровождаться тенезмами (тянущими судорожными болями в заднем
проходе), часто возникают ложные позывы. Примесь крови чаще всего незначительна (в виде кровяных точек или прожилок).
При пальпации живота отмечают спазм, реже — болезненность сигмовидной кишки, иногда — метеоризм. С первого дня
заболевания появляются признаки интоксикации: лихорадка, недомогание, головная боль, головокружение. Возможны сердечнососудистые расстройства, тесно связанные с синдромом интоксикации (экстрасистолия, систолический шум на верхушке,
приглушённость тонов сердца, колебания АД, наличие изменений на электрокардиограмме, свидетельствующие о диффузных
изменениях миокарда левого желудочка, перегрузке правых отделов сердца).
Длительность клинической симптоматики при неосложнённом течении острого шигеллёза — 5-10 дней.
102.
Диагностика и лечение кишечных инфекцийКЛИНИЧЕСКАЯ КАРТИНА
Гастроэнтероколитический вариант острого шигеллёза
Клинические особенности этого варианта заключаются в том, что начало болезни напоминает ПТИ, а
в разгар заболевания появляются и выходят на первый план симптомы колита. Гастроэнтеритический
вариант острого шигеллёза по течению соответствует начальному периоду гастроэнтероколитического
варианта. Отличие состоит в том, что в более поздние сроки симптомы энтероколита не доминируют и
клинически этот вариант течения более сходен с ПТИ. При ректороманоскопии обычно наблюдают
менее выраженные изменения.
Стёртое течение острого шигеллёза
Характеризуется кратковременными и невыраженнными клиническими симптомами (1-2-кратное
расстройство стула, кратковременные боли в животе), отсутствием симптомов интоксикации.
Подобные случаи заболевания диагностируют при определении ректороманоскопических изменений
(как правило, катаральных) и выделении шигелл из испражнений. О затяжном течении
острого шигеллёза говорят, когда основные клинические симптомы не исчезают или
возобновляются после кратковременной ремиссии в течение 3 н е д - 3 мес.
103.
Диагностика и лечение кишечных инфекцийКЛИНИЧЕСКАЯ КАРТИНА
Бактерионосительство
К этой форме инфекционного процесса относят случаи, когда отсутствуют клинические симптомы на
момент обследования и в предшествовавшие 3 мес, при ректороманоскопии и выделении шигелл из
испражнений не выявляют изменений на слизистой оболочке толстой кишки. Бактерионосительство
может быть реконвалесцентным (сразу после перенесённого острого шигеллёза) и субклиническим, если
шигеллы выделяют у лиц, не имеющих клинических проявлений и изменений в слизистой оболочке
дистального отдела толстой кишки.
Хронический шигеллёз
Хроническое заболевание регистрируют в тех случаях, когда патологический процесс продолжается более
3 мес. Хронический шигеллёз по клиническому течению подразделяют на две формы —
рецидивирующую и непрерывную. При рецидивирующей форме периоды обострений сменяются
ремиссией.
Обострения характеризуются клинической симптоматикой, характерной для
колитического или гастроэнтероколитического варианта острого шигеллёза, но слабой
выраженностью интоксикации. При непрерывном течении колитический синдром не стихает, отмечают
гепатомегалию. При хроническом шигеллёзе на ректороманоскопии обнаруживают также умеренные
воспалительные и атрофические изменения.
104.
Диагностика и лечение кишечных инфекцийДИФФЕРЕНЦИАЛЬНАЯ ДИАГНОСТИКА ШИГЕЛЛЕЗА
Нозоформа
острый шигеллёз
Сальмонеллёз с колитическим
синдромом
острый аппендицит
мезентериальный
тромбоз
ЯК острая/подострая
форма
рак дистального
отдела толстой
кишки
Эпидемический
анамнез
Контакт с больным,
употребление
необеззараженной воды
Групповой характер
заболевания, нарушение
правил хранения и приготовления
пищи, питание
в «Общепите»
-
Возможно переедание
-
-
Возраст, анамнез
жизни
Любой
Любой
Любой
60 лет и старше, ИБС,
атеросклероз
Молодой, средний, эпизоды
диареи с тенденцией
к утяжелению
Средний, старший,
примесь крови в кале
Острое, одновременно
боли в животе, рвота,
лихорадка, затем диарея
Острое, боли в животе,
затем рвота, диарея,
лихорадка
Острое, боли в животе,
рвота, диарея, лихорадка
через 1-2 дня
Острое, подострое, диарея,
лихорадка
Боли в животе, диарея,
лихорадка непостоянно
Схваткообразные в
эпигастрии, затем смещаются
в нижнюю часть
живота
Постоянные усиливаются
при кашле, движении
в правой подвздошной
области, иногда в нижней
части живота
Разлитые, преимущественно
слева, режущие
Слабо выражены, разлитые
В левой половине
живота, тупые,
непостоянные
Признак
Острое, одновременно
Развитие болезни боли в животе, диарея,
лихорадка
Боли в животе
Схваткообразные в левой
подвздошной области
105.
Диагностика и лечение кишечных инфекцийДИФФЕРЕНЦИАЛЬНАЯ ДИАГНОСТИКА ШИГЕЛЛЕЗА
Не характерна
Возможна в первые дни
Стул
Скудный, со слизью и
кровью, частый
Обильный, зелёный, с
Кашицеобразный, без
резким запахом, иногда
примесей, до 4-6 раз
со слизью, частый
Кашицеобразный,
жидкий,
с примесью алой
крови
Жидкий, со слизью,
Обильный, частый, жидкий, кровью и гноем,
с кровью («мясные
которые
помои»)
сохраняются после
оформления стула
Тенезмы,
ложные
позывы
Характерны
Не характерны
Не наблюдаются
Не характерны
Не характерны
Не характерны
Вздут, безболезненный
Мягкий, болезненность
слева
Не изменена
Слабо болезненна
Плотная, утолщённая,
неподвижная
Кольцевидные
геморрагии,
некроз
Резкий отёк,
кровоточивость,
налёт фибрина,
эрозии, язвы
Опухоль с некрозом,
кровотечением, перифокальным
воспалением
Рвота
Возможна вначале
1-2 раза
Часто, возможна
примесь
крови
Постоянно,
многократная
Живот
Мягкий, втянут
Вздут
Напряжён, локальная
болезненность,
Вздут, разлитая
симптомы
болезненность
раздражения брюшины
Сигма
Спазмирована,
болезненна
Болезненная
Не изменена
Эндоскопия
Изменения, типичные
для шигеллёза
Катаральный,
катаральноНорма
геморрагический колит
Не характерна
106.
Диагностика и лечение кишечных инфекцийОСЛОЖНЕНИЯ.
ИТШ, серозный (пропотевание кишечной стенки) или перфоративный (при циркулярных некрозах или глубоких
язвенных дефектах) перитониты, острый панкреатит. Расстройства моторики могут привести к развитию
инвагинации кишечника. Описаны кишечные и желудочные кровотечения, миокардит, полиартрит, нефрит,
иридоциклит, полиневрит, токсический гепатит. У больных с неблагоприятным преморбидным фоном и тяжёлым
течением шигеллёза развиваются пневмония и острая сердечно-сосудистая недостаточность, представляющие
собой одну из основных причин летальных исходов.
107.
Диагностика и лечение кишечных инфекцийИСХОД
Прогноз преимущественно благоприятный, при своевременном комплексном
лечении острых форм шигеллеза, хронизация процесса крайне редка. В некоторых
случаях после перенесения инфекции могут сохраниться остаточные
функциональные нарушения работы толстого кишечника.
108.
Диагностика и лечение кишечных инфекцийМЕТОДЫ ЛАБОРАТОРНОГО И ИНСТРУМЕНТАЛЬНОГО ИССЛЕДОВАНИЯ
Клинически диагноз шигеллёза можно установить только в случаях типичного колитического варианта течения болезни. Для
уточнения диагноза в не подтверждённых лабораторно случаях проводят:
Ректороманоскопию, которая во всех случаях шигеллёза выявляет картину колита (катарального, геморрагического или эрозивноязвенного) с поражением слизистой оболочки дистального отдела толстой кишки, часто сфинктерит. Гастроэнтеритический и
гастроэнтероколитический варианты диагностируют только в случае лабораторного подтверждения.
Наиболее достоверный метод лабораторной диагностики шигеллёза — выделение копрокультуры шигелл. Для исследования
проводят забор частиц испражнений, содержащих слизь и гной (но не кровь), возможен забор материала из прямой кишки
ректальной трубкой. Для посева используют 20% жёлчный бульон, комбинированную среду Кауфмана, селенитовый бульо.
Результаты бактериологического исследования можно получить не ранее чем через 3 - 4 дня от начала заболевания.
В некоторых случаях гастроэнтеритов, предположительно шигеллёзной этиологии, проводят бактериологическое исследование
промывных вод желудка. Диагноз может быть подтверждён также серологическими методами.
Также используют ИФА, РКА.
Вспомогательный метод диагностики — копрологическое исследование, при котором обнаруживают повышенное содержание
нейтрофилов, их скопления, наличие эритроцитов и слизи в мазке.
Из инструментальных методов основное значение имеют эндоскопические (ректороманоскопия и колонофиброскопия), которые
подтверждают характерные изменения слизистой оболочки толстой кишки.
УЗИ и рентгенологические методы исследования применяются с целью дифференциальной диагностики.
109.
Диагностика и лечение кишечных инфекций.Организация оказания медицинской помощи пациентам с инфекционными заболеваниями.
Роль фельдшера в ранней диагностике инфекционных заболеваний.
ОЦЕНКА ЭФФЕКТИВНОСТИ И БЕЗОПАСТНОСТИ ПРОВОДИМОГО
ЛЕЧЕНИЯ
Индикаторы эффективности лечения:
• купирование симптомов заболевания;
• купирование осложнений (при их наличии)
110.
Диагностика и лечение кишечных инфекций.ПРИНЦИПЫ НЕМЕДИКАМЕНТОЗНОГО И МЕДИКАМЕНТОЗНОГО ЛЕЧЕНИЯ.
Немедикаментозное лечение:
Режим. Диета
При тяжёлом и среднетяжёлом течении показан постельный, при лёгком — палатный режим. В остром
периоде при значительных кишечных расстройствах назначают стол № 4 по Певзнеру. При улучшении
состояния, уменьшении дисфункции кишечника и появлении аппетита больных переводят на стол № 2
или № 13, а за 2 - 3 дня до выписки из стационара — на общий стол № 15.
111.
Диагностика и лечение кишечных инфекцийПРИНЦИПЫ НЕМЕДИКАМЕНТОЗНОГО И МЕДИКАМЕНТОЗНОГО ЛЕЧЕНИЯ.
Медикаментозное лечение:
Назначать больному антибактериальный препарат необходимо с учётом сведений о чувствительности к
нему штаммов шигелл, выделяемых от больных в данной местности в последнее время.
• Продолжительность курса этиотропной терапии определяется улучшением состояния больного. При
среднетяжёлой форме инфекции курс этиотропной терапии ограничен 3 - 4 днями, при тяжёлой — 5 - 6
днями.
• При гастроэнтеритическом варианте шигеллёза этиотропное лечение не показано.
Больным с лёгкой формой шигеллёза в разгаре заболевания назначают фуразолидон. При среднетяжёлом
течении шигеллёза назначают препараты группы фторхинолонов, при тяжёлом течении — офлоксацин или
ципрофлоксацин
112.
Диагностика и лечение кишечных инфекцийПРИНЦИПЫ НЕМЕДИКАМЕНТОЗНОГО И МЕДИКАМЕНТОЗНОГО
ЛЕЧЕНИЯ.
Медикаментозное лечение:
Патогенетические средства
• Проводят регидратационную терапию. При лёгкой форме — пероральное применение растворов оралит,
регидрон, циклоглюкосолан. При среднетяжёлом и тяжёлом течении применяют в /в введение
кристаллоидных р-ров хлосоль, квартасоль, трисоль с учётом степени обезвоживания и массы тела
больного
• При отсутствии выраженного обезвоживания и признаках интоксикации применяют 5% раствор глюкозы
и плазмозаменители
• Для связывания и выведения токсина из кишечника назначают один из энтеросорбентов
• Кишечные антисептики
• Для коррекции и компенсации пищеварительной недостаточности применяют ферментные препараты
• В остром периоде для купирования спазма толстой кишки назначают дротаверина гидрохлорид (но-шпа)
• В течение всего периода лечения рекомендуют комплекс витаминов
113.
Диагностика и лечение кишечных инфекцийТАКТИКА ВЕДЕНИЯ ПАЦИЕНТОВ
Госпитализация пациентов со средне - тяжелыми, тяжелыми и осложненными формами
заболевания, по эпидемиологическим показаниям.
Амбулаторное лечение пациентов с легкой формой заболевания при отсутствии эпидемиологических,
социальных показаний для госпитализации.
Примерные сроки нетрудоспособности
При лёгкой форме — 7 - 1 0 дней, при среднетяжёлой — до 16-18 дней, при тяжёлой форме и
осложнениях — до месяца и более. Пациентов из декретированной группы не допускают к работе, пока
не получат двух отрицательных результатов бактериологического исследования испражнений.
Диспансерное наблюдение
Диспансерному наблюдению подлежат больные хронической дизентерией, работники пищевых
предприятий и лица, к ним приравненные (в течение 3 мес, а при хронической дизентерии — в течение
6 мес).
114.
Диагностика и лечение кишечных инфекцийПОКАЗАНИЯ К ОКАЗАНИЮ СПЕЦИАЛИЗИРОВАННОЙ
МЕДИЦИНСКОЙ ПОМОЩИ В СТАЦИОНАРНЫХ УСЛОВИЯХ
Показания к госпитализации:
Клинические: тяжёлое и среднетяжёлое течение болезни, наличие выраженных сопутствующих
заболеваний.
Эпидемиологические: лица декретированных групп.
115.
Диагностика и лечение кишечных инфекцийХолера – это острое инфекционное антропонозное заболевание,
характеризующееся эпидемическим распространением, с фекальнооральным механизмом передачи, вызываемое Vibrio cholerae
серогруппы О1 и серогруппы О139. Холера клинически проявляется
от вибрионосительства и бессимптомных форм до тяжелого синдрома
дегидратации вследствие потери жидкости с водянистыми
испражнениями и рвотными массами, приводящего к летальному
исходу. Это одно из заболеваний, требующих обязательного
уведомления по Международным Правилам Здравоохранения.
А00 – Холера
А00.0 - Холера, вызванная холерным вибрионом 01, биовар cholerae
А00.1 - Холера, вызванная холерным вибрионом 01, биовар eltor
А00.9 - Холера неуточненная
116.
Диагностика и лечение кишечных инфекцийЭТИОЛОГИЯ
Возбудитель холеры Vibrio cholerae относится к роду Vibrio семейства Vibrionaceae.
Возбудители холеры представляют собой короткие изогнутые грамотрицательные палочки (1,5-3 мкм длиной и 0,2-0,6 мкм
шириной), высокоподвижные благодаря наличию полярно расположенного жгутика. Спор и капсул не образуют,
располагаются параллельно, в мазке напоминают стаю рыб, культивируют их на щелочных питательных средах
Холерные вибрионы хорошо выживают при низкой температуре; во льду сохраняются до 1 мес, в морской воде — до 47 сут, в
речной воде — от 3-5 дней до нескольких недель, в почве — от 8 дней до 3 мес, в испражнениях — до 3 сут, на сырых овощах — 2-4
дня, на фруктах — 1-2 дня. Холерные вибрионы при 80 °С погибают через 5 мин, при 100 °С - моментально; высокочувствительны к
кислотам, высушиванию и действию прямых солнечных лучей, под действием хлорамина и других дезинфектантов погибают через
5-15 мин, хорошо и долго сохраняются и даже размножаются в открытых водоёмах и сточных водах, богатых органическими
веществами.
Источник возбудителя инфекции — человек (больной и вибриононоситель). Особенно опасны сохраняющие социальную
активность больные со стёртой и лёгкой формами болезни.
Механизм передачи инфекции — фекально-оральный. Пути передачи — водный, алиментарный, контактно-бытовой. Водный путь
имеет решающее значение для быстрого эпидемического и пандемического распространения холеры. При этом не только питьё
воды, но также использование её для хозяйственных нужд (мытьё овощей, фруктов и т.п.), купание в заражённом водоёме, а также
употребление рыбы, раков, креветок, устриц, выловленных там и не прошедших термической обработки, могут приводить к
заражению холерой.
После перенесённой болезни вырабатывается антимикробный и антитоксический иммунитет, который длится от 1 до 3 лет.
117.
Диагностика и лечение кишечных инфекцийЭТИОЛОГИЯ
118.
Диагностика и лечение кишечных инфекцийПАТОГЕНЕЗ
Входными воротами инфекции является пищеварительный тракт. Заболевание развивается лишь тогда, когда
возбудители преодолевают желудочный барьер (обычно это наблюдается в периоде базальной секреции, когда
рН желудочного содержимого близок к 7), достигают тонкой кишки, где начинают интенсивно размножаться и
выделять экзотоксин. Энтеротоксин или холероген определяет возникновение основных проявлений холеры.
Холерный синдром связан с наличием у данного вибриона двух веществ: белкового энтеротоксина —
холерогена (экзотоксина) и нейраминидазы. Холероген связывается со специфическим рецептором
энтероцитов — ганглиозидом. Под действием нейраминидазы из ганглиозидов образуется специфический
рецептор. Комплекс холерогенспецифический рецептор активирует аденилатциклазу, которая инициирует
синтез цАМФ. Аденозинтрифосфат регулирует посредством ионного насоса секрецию воды и электролитов из
клетки в просвет кишечника. В результате слизистая оболочка тонкой кишки начинает секретировать
огромное количество изотонической жидкости, которая не успевает всасываться в толстой кишке, —
развивается изотоническая диарея. С 1 л испражнений организм теряет 5 г хлорида натрия, 4 г гидрокарбоната
натрия, 1 г хлорида калия. Присоединение рвоты увеличивает объём теряемой жидкости.
В результате уменьшается объём плазмы, сокращается объём циркулирующей крови и она сгущается.
Жидкость перераспределяется из интерстициального во внутрисосудистое пространство. Возникают
гемодинамические расстройства, нарушения микроциркуляции, следствием которых становятся
дегидратационный шок и ОПН. Развивается метаболический ацидоз, который сопровождается
судорогами. Гипокалиемия вызывает аритмию, гипотензию, изменения в миокарде и атонию кишечника.
119.
Диагностика и лечение кишечных инфекцийКЛАССИФИКАЦИЯ
По выраженности клинических проявлений различают стёртую, лёгкую, средней тяжести, тяжёлую и
очень тяжёлую формы, определяющиеся степенью обезвоживания.
В.И. Покровский выделяет следующие степени обезвоживания:
• I степень, когда больные теряют объём жидкости, равный 1-3% массы тела (стёртые и лёгкие
формы);
• II степень — потери достигают 4-6% (форма средней тяжести);
• III степень — 7-9% (тяжёлая);
• IV степень обезвоживания с потерей свыше 9% соответствует очень тяжёлому течению холеры.
В настоящее время I степень обезвоживания встречается у 50-60% больных, II - у 20-25%, III - у 810%, IV - у 8-10%
120.
Оценка тяжести дегидратации у взрослых и детейСтепень обезвоживания, % потери массы тела
Признак
стёртая и лёгкая
средней тяжести
тяжёлая
очень тяжёлая
1-3
4-6
7-9
10 и более
Стул
До 10 раз
До 20 раз
Более 20 раз
Без счёта
Рвота
До 5 раз
До 10 раз
До 20 раз
Многократная
(неукротимая)
Жажда
Слабо
Умеренно выраженная
Резко выраженная
Неутолимая (или не может пить)
Диурез
Норма
Снижен
Олигурия
Анурия
Судороги
Нет
Икроножных мышц,
кратковременные
Продолжительные и
болезненные
Генерализованные
клонические
Состояние
Удовлетворительное
Средней тяжести
Тяжёлое
Очень тяжёлое
Глазные яблоки
Норма
Норма
Запавшие
Резко запавшие
Слизистые оболочки
рта, язык
Влажные
Суховатые
Сухие
Сухие, резко гиперемированы
Дыхание
Норма
Норма
Умеренное тахипноэ
Тахипноэ
121.
Оценка тяжести дегидратации у взрослых и детейЦианоз
Тургор кожи
Нет
Норма
Носогубного
треугольника
Акроцианоз
Резко выражен,
диффузный
Норма
Снижен (кожная
Резко снижен
складка
(кожная складка
расправляется >1 с) расправляется >2 с)
До 100 в минуту
До 120 в мин
Выше 120 в
минуту,
нитевидный
АДс сист , мм рт.ст Норма
До 100
60-100
Меньше 60
рН крови
7,36-7,40
7,36-7,40
7,30-7,36
Менее 7,3
Голосовое
звучание
Сохранено
Сохранено
Охриплость голоса Афония
Относительная
Норма (до 1025)
плотность плазмы
1026-1029
1030-1035
1036 и более
Гематокрит, %
46-50
50-55
Выше 55
Пульс
Норма
Норма (40-46%)
122.
Диагностика и лечение кишечных инфекцийКЛИНИЧЕСКАЯ КАРТИНА
Инкубационный период от нескольких часов до 5 сут, чаще 2-3 дня.
Заболевание начинается остро, без лихорадки и продромальных явлений. Первыми клиническими признаками являются внезапный
позыв на дефекацию и отхождение кашицеобразных или с самого начала водянистых испражнений. В последующем эти
императивные позывы повторяются. Испражнения теряют каловый характер и часто имеют вид рисового отвара:
полупрозрачные, мутновато-белой окраски, иногда с плавающими хлопьями серого цвета, без запаха или с запахом пресной воды.
Больной отмечает урчание и неприятные ощущения в пупочной области.
У больных с лёгкой формой холеры дефекация повторяется не чаще 3-5 раз в сутки, общее самочувствие остаётся
удовлетворительным, незначительны ощущения слабости, жажды, сухости во рту. Длительность болезни ограничивается 1-2 днями.
При средней тяжести (обезвоживание II степени) болезнь прогрессирует, к диарее присоединяется рвота, нарастающая по
частоте. Рвотные массы имеют такой же вид рисового отвара, как и испражнения. Характерно, что рвота не сопровождается какимлибо напряжением и тошнотой. С присоединением рвоты эксикоз быстро прогрессирует. Жажда становится мучительной, язык
сухим, с «меловым налётом», кожа, слизистые оболочки глаз и ротоглотки бледнеют, тургор кожи снижается. Стул до 10 раз в сутки,
обильный, в объёме не уменьшается, а увеличивается. Возникают единичные судороги икроножных мышц, кистей, стоп,
жевательных мышц, нестойкий цианоз губ и пальцев рук, охриплость голоса. Развиваются умеренная тахикардия, гипотензия,
олигурия, гипокалиемия. Заболевание в этой форме длится 4-5 дней.
123.
Диагностика и лечение кишечных инфекцийКЛИНИЧЕСКАЯ КАРТИНА
Тяжёлая форма холеры (III степень обезвоживания) характеризуется резко выраженными признаками эксикоза
вследствие обильного (до 1-1,5 л за одну дефекацию) стула, который становится таким уже с первых часов болезни, и
такой же обильной и многократной рвоты. Больных беспокоят болезненные судороги мышц конечностей и живота,
которые по мере развития болезни переходят от редких клонических в частые и даже сменяются тоническими
судорогами. Голос слабый, тонкий, часто чуть слышный. Тургор кожи снижается, собранная в складку кожа долго не
расправляется. Кожа кистей и стоп становится морщинистой («рука прачки»). Лицо принимает характерный для
холеры вид: заострившиеся черты, запавшие глаза, цианоз губ, ушных раковин, мочек ушей, носа.
Очень тяжёлая форма холеры (ранее называвшаяся алгидной) отличается бурным внезапным развитием болезни,
начинающейся с массивных беспрерывных дефекаций и обильной рвоты. Через 3-12 ч у больного развивается
тяжёлое состояние алгида, которое характеризуется снижением температуры тела до 34-35,5 °С, крайним
обезвоживанием (больные теряют до 12% массы тела — дегидратация IV степени), одышкой, анурией и нарушениями
гемодинамики по типу гиповолемического шока
124.
Диагностика и лечение кишечных инфекцийДИФФЕРЕНЦИАЛЬНАЯ ДИАГНОСТИКА ХОЛЕРЫ
пидемиологичес Нозологическая форма
кие
и клинические холера
признаки
Контингент
Жители эндемичных
Регионов и приезжие из них
ПТИ
Нет специфики
Употребление
пищевых
Употребление
продуктов,
Эпидемиологиче необеззараженной воды, мытьё в ней
приготовленных
ские
овощей и фруктов, купание в загрязнённых
и хранившихся
данные
водоёмах, контакт
с нарушением
с больным
гигиенических
норм
Очаговость
Первые
симптомы
шигеллез
Нет специфики
вирусная
диарея
диарея путешественников
Нет специфики
Туристы в развивающиеся
страны с жарким
климатом
Контакт с больным,
употребление
главным образом
Контакт с
молочнокислых
больным
продуктов, нарушение
личной
гигиены
Употребление воды,
продуктов питания,
приобретённых у уличных
торговцев
Возможна
среди контактных
лиц,
употреблявших
подозрительный
продукт
Возможна по общим
эпидемиологическим
признакам
Часто по общим
эпидемиологическим
признакам
Часто среди
употреблявших
тот же
подозрительный
продукт
Жидкий стул
Боли в животе,
Боли в эпигастрии,
жидкий
рвота
стул
Часто среди
контактных
лиц
Боли в эпигастрии,
Боли в эпигастрии, рвота
рвота
125.
Диагностика и лечение кишечных инфекцийДИФФЕРЕНЦИАЛЬНАЯ ДИАГНОСТИКА ХОЛЕРЫ
Рвота
Жидкий стул
Тенезмы,
ложные
позывы
Лихорадка,
интоксикация
Отсутствуют
Часто, одновременно
с диспепсическим
синдромом или
раньше его
Часто, одновременно
или раньше
диспепсического
синдрома
Характер стула
Бескаловый,
водянистый, без
характерного
запаха
Каловый, жидкий,
зловонный
Каловый или
Каловый,
бескаловый («ректальный жидкий,
плевок») со
пенистый,
слизью и
с кислым
кровью
запахом
Каловый жидкий, часто
со слизью
Вздут, слабоболезненный
Умеренно болезненный
I-III степени
HI степени
Последующие
симптомы
Живот
Вздут, безболезненный
Вздут, болезнен
в эпи- и мезогастрии
Втянут,
болезненный
в левой подвздошной
области
Обезвоживание
II-IV степени
I-III степени
Возможно,
HI степени
Жидкий стул
Жидкий стул
Часто,
выражены
умеренно
Характерны,
одновременно
с диспепсическим
синдромом
126.
Диагностика и лечение кишечных инфекцийОСЛОЖНЕНИЯ.
Вследствие нарушений гемостаза и микроциркуляции у больных старших
возрастных групп наблюдают инфаркт миокарда, мезентериальный тромбоз,
острую недостаточность мозгового кровообращения. Возможны флебиты (при
катетеризации вен), у тяжёлых больных нередко возникает пневмония
127.
Диагностика и лечение кишечных инфекцийИСХОД
При своевременном и полном лечении после подавления инфекции наступает
выздоровление. В настоящее время современные препараты эффективно действуют
на холерный вибрион, а регидратационная терапия способствует профилактике
осложнений.
128.
Диагностика и лечение кишечных инфекцийМЕТОДЫ ЛАБОРАТОРНОГО И ИНСТРУМЕНТАЛЬНОГО
ИССЛЕДОВАНИЯ
Клинический диагноз при наличии эпидемиологических данных и характерной клинической картины (начало болезни с диареи с
последующим присоединением рвоты, отсутствие болевого синдрома и лихорадки, характер рвотных масс) не сложен, однако лёгкие,
стёртые формы болезни, особенно единичные случаи, часто просматриваются. В этих ситуациях решающее значение имеет
лабораторная диагностика.
Основным и решающим методом лабораторной диагностики холеры является бактериологическое исследование. В качестве
материала используют испражнения и рвотные массы, на вибриононосительство исследуют испражнения; у лиц, погибших от
холеры, берут лигированный отрезок тонкой кишки и жёлчного пузыря.
При проведении бактериологического исследования необходимо соблюдать три условия:
• как можно быстрее произвести посев материала от больного (холерный вибрион сохраняется в испражнениях короткий срок);
• посуда, в которую берут материал, не должна обеззараживаться химическими веществами и не должна содержать их следы, так как
холерный вибрион к ним очень чувствителен;
• исключить возможность загрязнения и заражения окружающих.
Материал должен быть доставлен в лабораторию в течение первых 3 ч; если это невозможно, используют среды-консерванты
(щелочная пептонная вода и др.). Материал собирают в индивидуальные отмытые от дезинфицирующих растворов судна, на дно
которых помещают меньший по размерам, обеззараженный кипячением сосуд или листы пергаментной бумаги. При пересылке
материал укладывают в металлическую тару и перевозят в специальном транспорте с сопровождающим. Каждый образец снабжают
этикеткой, на которой указывают имя и фамилию больного, название образца, место и время взятия, предполагаемый диагноз
и фамилию забравшего материал. Результаты экспресс-анализа получают через 2-6 ч (ориентировочный ответ), ускоренного анализа
— через 8-22 ч (предварительный ответ), полного анализа — через 36 ч (заключительный ответ).
Серологические методы имеют вспомогательное значение и могут применяться в основном для ретроспективной диагностики. С
этой целью может быть использована микроагглютинация в фазовом контрасте, РНГА, но лучше — определение титра
вибриоцидных антител или антитоксинов (антитела к холерогену определяют ИФА или иммунофлюоресцентным методом).
129.
Диагностика и лечение кишечных инфекцийПРИНЦИПЫ НЕМЕДИКАМЕНТОЗНОГО И МЕДИКАМЕНТОЗНОГО ЛЕЧЕНИЯ.
Медикаментозное лечение:
Основные принципы терапии:
• возмещение потери жидкости и восстановление электролитного состава организма;
• воздействие на возбудитель.
Лечение необходимо начинать в первые часы от начала болезни.
Препаратами выбора являются: фторхинолоны, курс – 5 дней
Патогенетические средства
Терапия включает первичную регидратацию (возмещение потерь воды и солей до начала лечения) и корригирующую
компенсаторную регидратацию (коррекция продолжающихся потерь воды и электролитов). Регидратация
рассматривается как реанимационное мероприятие. В приёмном покое в течение первых 5 мин у больного необходимо
измерить частоту пульса, АД, массу тела, взять кровь для определения гематокрита или относительной плотности
плазмы крови, содержания электролитов, кислотно-основного состояния, коагулограммы, а затем начать струйное
введение солевых растворов.
130.
Диагностика и лечение кишечных инфекцийОЦЕНКА ЭФФЕКТИВНОСТИ И БЕЗОПАСТНОСТИ ПРОВОДИМОГО
ЛЕЧЕНИЯ
Индикаторы эффективности лечения:
• купирование симптомов заболевания;
• купирование осложнений (при их наличии)
131.
Диагностика и лечение кишечных инфекцийТАКТИКА ВЕДЕНИЯ ПАЦИЕНТОВ
Выписку больных холерой (вибриононосителей) производят после их
выздоровления, завершения регидратационной и этиотропной терапии и получения трёх
отрицательных результатов бактериологического обследования.
Перенёсших холеру или вибриононосительство после выписки из стационаров допускают к
работе (учёбе), независимо от профессии ставят на учёт в территориальных отделах
эпидемиологического надзора и КИЗ поликлиник по месту жительства. Диспансерное
наблюдение осуществляется в течение 3 мес. Перенёсшие холеру подлежат
бактериологическому обследованию на холеру: в первый месяц проводят бактериологическое
исследование испражнений один раз в 10 дней, в дальнейшем — один раз в месяц.
При выявлении вибриононосительства у реконвалесцентов их госпитализируют для лечения в
инфекционную больницу, после чего диспансерное наблюдение за ними возобновляют.
Перенёсших холеру или вибриононосительство снимают с диспансерного учёта, если
холерные вибрионы не выделяются на протяжении диспансерного наблюдения.
132.
Диагностика и лечение кишечных инфекцийПОКАЗАНИЯ К ОКАЗАНИЮ СПЕЦИАЛИЗИРОВАННОЙ
МЕДИЦИНСКОЙ ПОМОЩИ В СТАЦИОНАРНЫХ УСЛОВИЯХ
Обязательной госпитализации подлежат все больные холерой или с подозрением на неё!
133.
Диагностика и лечение кишечных инфекцийРотавирусный гастроэнтерит - острое антропонозное инфекционное заболевание
с фекально-оральным механизмом передачи, вызываемое ротавирусами, и
характеризующееся поражением желудочно-кишечного тракта по типу
гастроэнтерита с развитием синдрома дегидратации
А08.0 - Ротавирусный гастроэнтерит
134.
Диагностика и лечение кишечных инфекций..
ЭТИОЛОГИЯ
Возбудитель заболевания ротавирус. Ротавирусы относятся к роду Rotavirus семейства Reoviridae
Ротавирусная инфекция распространена во всем мире. Источником инфекции является только
человек (больной манифестной формой или вирусовыделитель), в фекалиях содержится огромное
количество вирусов
Ротавирусы млекопитающих и птиц в естественных условиях для человека не патогенны. Фекальнооральный механизм передачи реализуется чаще водным и контактно-бытовым путями, реже пищевым (молоко, молочные продукты, заменители грудного молока), дискутируется возможность
аэрозольного пути передачи (в первую очередь с рвотными массами).
Вирус высокоустойчив во внешней среде, при замораживании сохраняет жизнеспособность в течение
нескольких месяцев, при кипячении быстро погибает. Ротавирусы являются важнейшей причиной
острых кишечных инфекций с развитием синдрома дегидратации у детей (до 60-75% всех диарей) в
странах, где не осуществляется вакцинопрофилактика РВИ.
РВИ может протекать в виде спорадических случаев, групповых заболеваний и массовых вспышек. В
стационарах возможно нозокомиальное инфицирование контактно-бытовым путем, причем нередко
источником инфекции является медперсонал. Ротавирусным гастроэнтеритом болеют люди любого
возраста, но максимальная заболеваемость отмечается у детей первых двух лет жизни (с максимум от
6 до 18 месяцев), людей пожилого возраста и иммунокомпроментированных лиц.
135.
Диагностика и лечение кишечных инфекций.ПАТОГЕНЕЗ
Ротавирусы вызывают прямое поражение кишечного эпителия. Благодаря устойчивости к воздействию
протеолитических ферментов и желчи вирусы достигают эпителия тонкой кишки и внедряются в
высокодифференцированные клетки ворсинок. Проникновение внутрь клетки вызывает повреждение
цитоскелета эпителиоцитов и их отторжение с последующим замещением незрелыми клетками. Возможно
поражение до 2/3 слизистой оболочки тонкой кишки. В результате этого нарушаются ферментативные
системы энтероцитов, расщепляющие углеводы, в первую очередь лактозу, что приводит к развитию
вторичной лактазной недостаточности.
Накопление избыточного количества негидролизованных углеводов сопровождается повышением
осмотического давления в толстой кишке, нарушением реабсорбции воды и электролитов. А в процессе
ферментации нерасщепленных дисахаридов кишечной микрофлорой образуется большое количество
органических кислот, водорода, углекислого газа, воды, что ведет к повышению газообразования в кишечнике
и снижению pH кишечного содержимого. Возникает водянистая (осмотическая диарея), обусловленная
ферментативной дисфункцией.
136.
Диагностика и лечение кишечных инфекцийКЛАССИФИКАЦИЯ
По типу: типичная (манифестная форма); атипичная (латентная форма, или носительство)
По форме: моноинфекция; сочетанная форма (с другими инфекционными заболеваниями)
По тяжести: легкая форма; среднетяжелая; тяжелая
По наличию осложнений: без осложнений; с осложнениями (синдром дегидратации, гиповолемический шок,
острая почечная недостаточность; инвагинация, гепатит, панкреатит, кардиомиопатия, поражение ЦНС, токсикодистрофический синдром)
По характеру течения: острое (до 14 дней); хроническое
137.
Диагностика и лечение кишечных инфекцийКЛИНИЧЕСКАЯ КАРТИНА
Инкубационный период при РВИ составляет от 12 часов до 3-5 дней (чаще 1-2 дня). Основные симптомы РВГЭ — общая
интоксикация (лихорадка, вялость, рвота, головная боль) и изменения со стороны ЖКТ: боли в животе, частый водянистый стул
РВГЭ свойственны два варианта начала болезни: острый (около 90% больных), когда все основные симптомы появляются в 1-е
сутки болезни, и подострый, когда к 1-2-м симптомам (чаще боли в животе и интоксикация) на 2-3 день болезни присоединяются
диарея, рвота, лихорадка.
Большинство случаев РВИ начинается остро с повышения температуры до фебрильных цифр или даже гипертермии, однако
длительность лихорадки, несмотря на её выраженность, редко превышает 2-4 дня. Лихорадка сопровождается симптомами
интоксикации: слабостью, вялостью, снижением аппетита вплоть до развития анорексии и адинамии при тяжелых формах болезни.
Одним из первых, а нередко и ведущим проявлением РВИ, является рвота. Она может возникать одновременно с диареей или
предшествовать ей, носить повторный или многократный характер на протяжении 1-2 дней.
Диарейный синдром при РВИ является одним из наиболее важных и постоянных проявлений, в ряде случаев определяющих
клиническую картину заболевания. Стул обильный, водянистый, пенистый, желтого цвета, без видимых патологических примесей,
или с небольшим количеством прозрачной слизи, иногда отмечается характерный кислый запах испражнений. Частота стула в
среднем не превышает 4-7 раз в сутки, но может достигать и 15-25 раз
Продолжительность диареи в среднем колеблется от 3 до 7 дней, но может сохраняться и более продолжительное время (до 10-14
дней, чаще у детей раннего возраста). Для РВИ характерно сочетание диареи с явлениями метеоризма, которые наиболее выражены
у детей первого года жизни.
Болевой абдоминальный синдром при РВИ появляется в дебюте заболевания. Абдоминальные боли различной степени
выраженности могут носить разлитой характер или локализоваться в верхней половине живота, также могут встречаться эпизоды
схваткообразных болей.
138.
Диагностика и лечение кишечных инфекцийИСХОД
При своевременном и полном лечении после подавления инфекции наступает
выздоровление.
139.
Диагностика и лечение кишечных инфекцийМЕТОДЫ ЛАБОРАТОРНОГО И ИНСТРУМЕНТАЛЬНОГО
ИССЛЕДОВАНИЯ
Постановка диагноза ротавирусного гастроэнтерита требует анализа особенностей жалоб, эпиданамнеза,
данных физикального обследования и лабораторно-инструментальных исследований
Всем пациентам необходимо проведение этиологической диагностики: определение антигенов
ротавирусов (Rotavirus gr.A) в образцах фекалий, молекулярно-биологическое исследование фекалий на
ротавирусы (Rotavirus gr.A), определение РНК ротавирусов (Rotavirus gr.A) в образцах фекалий методом
ПЦР, иммунохроматографическое экспресс-исследование кала на ротавирус.
140.
Диагностика и лечение кишечных инфекцийПРИНЦИПЫ НЕМЕДИКАМЕНТОЗНОГО И МЕДИКАМЕНТОЗНОГО ЛЕЧЕНИЯ.
1.Назначение оральной регидратации с целью восстановления водноэлектролитного баланса (с учетом
возраста детей и массы тела)
2. Проведение инфузионной терапии (при неэффективности оральной регидратации) с целью регидратации,
дезинтоксикации и коррекции водно-электролитного баланса с использованием растворов для
внутривенного введения
3. Назначение адсорбирующих кишечных препаратов с цитомукопротективным действием с целью
проведения патогенетической терапии пациентам с РВГЭ
4. Назначение противодиарейных препаратов
141.
Диагностика и лечение кишечных инфекцийОЦЕНКА ЭФФЕКТИВНОСТИ И БЕЗОПАСТНОСТИ ПРОВОДИМОГО
ЛЕЧЕНИЯ
Индикаторы эффективности лечения:
• купирование симптомов заболевания;
• купирование осложнений (при их наличии)
142.
Диагностика и лечение кишечных инфекцийПОКАЗАНИЯ К ОКАЗАНИЮ СПЕЦИАЛИЗИРОВАННОЙ
МЕДИЦИНСКОЙ ПОМОЩИ В СТАЦИОНАРНЫХ УСЛОВИЯХ
Лечение пациентов с диагнозом РВИ легкой и средней степени тяжести при отсутствии факторов
риска осуществляется в амбулаторных условиях, тяжелой степени тяжести или среднетяжелой при
наличии сопутствующих заболеваний или факторов риска, а также по эпидемиологическим
показаниям - в условиях стационара, при развитии угрожающих жизни осложнений - в условиях
отделения реанимации и интенсивной терапии
143.
Диагностика и лечение кишечных инфекцийВирусный гепатит А– острое, циклически протекающее инфекционное заболевание,
характеризующееся кратковременными симптомами интоксикации, быстропроходящими
нарушениями печёночных функций, доброкачественностью течения.
Вирусный гепатит Е – острое инфекционное заболевание, вызываемое РНК-содержащим
вирусом, с преимущественным водным путем передачи, характеризующееся синдромом
интоксикации и нарушением функции печени.
В15 – Острый вирусный гепатит А
В17.2 – Острый гепатит Е
144.
Диагностика и лечение кишечных инфекцийЭТИОЛОГИЯ
Возбудитель ВГА РНК-содержащий вирус HAV (hepatitis A virus), относящийся к роду Hepatovirus в
составе семейства Picornaviridae.
ВГA типичная кишечная инфекция с фекально-оральным механизмом передачи возбудителя. Пути
передачи: водный, пищевой и бытовой. Факторы передачи различные пищевые продукты (в том числе
морепродукты, замороженные овощи и фрукты), не подвергшиеся термической обработке, а также
некипяченая вода. Крупные вспышки ВГA связаны с фекальным загрязнением водоѐмов (источников
водоснабжения) или с попаданием сточных вод в водопроводную сеть.
ВГA классический антропоноз, единственный источник (резервуар) возбудителя инфекции человек.
Вирус гепатита Е (HEV) имеет сферическую форму, диаметр около 32 нм и по своим свойствам близок
калицивирусам (семейство Caliciviridae). Геном вируса представлен однонитчатой РНК. Вирус быстро
разрушается под действием хлорсодержащих дезинфицирующих средств. Он менее устойчив в
окружающей среде, чем HAV. Источник инфекции больные с острой формой ВГЕ.
Основной путь передачи инфекции водный.
145.
Диагностика и лечение кишечных инфекцийПАТОГЕНЕЗ
Инкубационный период составляет от 15 до 50 дней, чаще около месяца. Начало острое, с
повышением температуры и явлениями со стороны ЖКТ (тошнота, рвота и др.).
Возможно появление желтухи на 5 – 7 день. Клиническое течение заболевания, как
правило, легкое, без особых осложнений; у детей до 5 ет – обычно бессимптомное.
Продолжительность заболевания 2 -3 недели. Хронические формы не развиваются. Вирус
проникает в организм через тонкий кишечник, в эпителиоцитах и лимфоидных клетках
которого он размножается. Оттуда кровью или лимфой попадает в печень, где
размножается в гепатоцитах, вызывая их разрушение. Разрушению гепатоцитов в
большей мере способствует развитие аутоиммунных реакций. Последующее развитие
иммунных реакций ограничивает распространение инфекции, при этом
высвобождающиеся из клеток вирионы с желчьюпопадают в просвет кишечника и
выводятся с испражнениями.
146.
Диагностика и лечение кишечных инфекцийКЛАССИФИКАЦИЯ
Вид ОВГ
ГепатитА
Гепатит Е
Критерий
этиологического
диагноза
а/HAV Ig M,
HAV - PНК
Форма тяжести
Критерии оценки тяжести
(в желтушный период)
Легкая
Симптомы интоксикации слабо выражены.
Билирубин общий до 100мкмоль/л, ПИдо 80%
Средняя
Симптомы интоксикации умеренно выражены.
Билирубин общий 100-180мкмоль/л, ПИ 60%-70%
Тяжелая
Симптомы интоксикации резко выражены.
Билирубин общий более 180мкмоль/л, ПИ 40%-60%
Злокачественная (при гепатите Е у
беременных женщин)
Печеночная энцефалопатия,
Геморрагический синдром(коагулопатия), сокращение
размеров печени.
Билирубин-протеидная диссоциация и билирубинферментная диссоциация.
a/HEV Ig M
HEV – РНК
147.
Диагностика и лечение кишечных инфекцийКЛАССИФИКАЦИЯ
По типу: типичная (желтушная) форма и атипичные формы (безжелтушная, стертая
и субклиническая формы)
По течению
острое до 3 месяцев;
затяжное до 6 месяцев
148.
Критерии оценки тяжести печеночной энцефалопатии:1 стадия –неврастенический синдром:
2 стадия –сомнолентность:
3 стадия – сопор:
4 стадия – кома:
5 стадия –глубокая терминальная кома:
психопатология: реакция на обращение и патологию сохранена, слабая способность к
сосредоточению, истощаемость, эйфория или депрессия;
неврологические симптомы: легкий тремор губ, гиперрефлексия
психопатология: реакция на обращение заторможена, неадекватное поведение,
дезориентация во времении пространстве, сонливость и беспокойство, спутанность
сознания;
неврологические симптомы: выраженный тремор губ, гиперрефлексия, нарушение
координации, скомканная речь
психопатология: реакция на обращение снижена, летаргия, пациента еще можно
разбудить, афазия, реакция на болевой раздражитель замедлена;
неврологические симптомы: клонические судороги, ригидность и спастичность мышц,
атаксия, тремор губ, гиперрефлексия
психопатология: реакции на обращение нет, реакция на болевое раздражениезаметна
снижена, и ненаправленная, словесный контакт отсутствует;
неврологические симптомы: спонтанная двигательная активность отсутствует или
движения некоординированные, клонические судороги, ригидность и спастичность мышц,
сохранены первичные реакции, положительный рефлекс Бабинского
психопатология: отсутствует реакция на болевой раздражитель;
неврологические симптомы: тонус мышц вялыйлибо положение сгибанияили
разгибания
149.
Диагностика и лечение кишечных инфекцийКЛИНИЧЕСКАЯ КАРТИНА
Жалобы:
В преджелтушный период:
повышение температуры тела (в 70-80% случаев)
снижение аппетита;
тошнота, рвота;
боли в животе, в области правого подреберья;
слабость, вялость, недомогание;
жидкий стул у детей младшего возраста.
В желтушный период:
желтушность кожи и склер;
возможен зуд;
боли в животе, в области правого подреберья;
потемнение цвета мочи;
осветление цвета стула.
Анамнез:
·
острое начало;
·
контакт с лабораторно-подтвержденным случаем гепатита А или Е, или же с желтушным больным за 10-50 дней до появления симптомов заболевания;
· цикличное течение заболевания с появления астено-вегетативного и диспепсического синдромов, повышения температуры тела, болей в животе, после чего
появление желтухи,улучшение самочувствия (при гепатите А).
Физикальное обследование
В преджелтушном периоде (продолжительность
периода 3- 10 дней)
·
·
увеличение печени;
при пальпации живота болезненность в области правого подреберья.
В желтушном периоде (продолжительность 2-3 недели)
·
желтушное окрашивание кожных покровов, склер, слизистой оболочки мягкого и твердого
неба, возможно обнаружение следов расчесов и геморрагических элементов, гепатомегалия.
Насыщенный цвет мочи по типу«пива» и обесцвеченный кал.
150.
Диагностика и лечение кишечных инфекцийДИФФЕРЕНЦИАЛЬНАЯ ДИАГНОСТИКА ВИРУСНЫХ ГЕПАТИТОВ А И Е
Диагноз
Обоснование для дифференциальной
диагностики
Обследования
Критерии исключения диагноза
Острый живот
Наличие болей в животе в первые дни болезни
ОАК, биохимический анализ крови
Боли в области правого подреберья, наличие инфильтрата в правой подвздошной
области. В общем анализе крови при остром животе – воспалительные изменения
(лейкоцитоз с нейтрофилезом). В биохимическом анализе крови –нормальный
уровеньАлАТ.
Надпеченочные желтухи (гемолитические
анемии)
Наличие желтухи
ОАК, биохимический анализ крови
При гемолитическойанемии цвет мочи и кала не меняется, уровень АлАТ в норме,
повышение уровня билирубина за счет неконьюгированной фракции, в общем
анализе крови - наличие анемии.
Наличие желтухи, боли в животе
При механической желтухе уровень билирубина повышен за счет
Биохимический анализ крови, ОАК, УЗИ
коньюгированной фракции, тогда как активность ферментов остается в норме или
органов брюшной полости, возможно КТ или слегка повышена.Выражен болевой синдром, при пальпации живота могут
МРТ
определяться образования. В ОАК возможен лейкоцитоз, нейтрофилез,
ускоренное СОЭ. В ряде случаев на УЗИ могут определяться тени конкрементов.
Механические желтухи
Функциональныегипербилирубинемии (синдром
Наличие желтухи
Жильбера)
Биохимический анализ крови
Встречается в подростковом и молодом возрасте. Гипербилирубинемия за счет
непрямой фракции, при нормальном уровне трансаминаз, нет гепатомегалии,
интоксикации. Гипербилирубинемия имеет волнообразный характер
Наличие гепатомегалии, болей в животе,
Печеночные желтухи (при иерсиниозе,
повышения уровня трансаминаз, иногда и
листериозе, инфекционном мононуклеозе и т.д.)
билирубина.
ОАК, биохимический анализ крови, ИФА,
бактериологический анализ.
Часто продолжительная лихорадка, нерезко выраженная гипербилирубинемия, в
ОАК нередко лейкоцитоз, нейтрофилез, значительно ускоренное СОЭ, поражение
других систем и органов. Окончательно диагноз выставляется после
151.
Диагностика и лечение кишечных инфекцийОСЛОЖНЕНИЯ.
Осложнениями вирусных гепатитов могут стать функциональные и воспалительные заболевания
желчных путей и печёночная кома, и, если, нарушение в работе желчевыводящих путей поддаётся
терапии, то печёночная кома является грозным признаком молниеносной формы гепатита,
заканчивающейся летальным исходом практически в 90% случаях.
152.
Диагностика и лечение кишечных инфекцийИСХОД
При своевременном и полном лечении наступает выздоровление.
153.
Диагностика и лечение кишечных инфекций.Организация оказания медицинской помощи пациентам с инфекционными заболеваниями.
Роль фельдшера в ранней диагностике инфекционных заболеваний.
МЕТОДЫ ЛАБОРАТОРНОГО И ИНСТРУМЕНТАЛЬНОГО ИССЛЕДОВАНИЯ
Лабораторные исследования:
Биохимическое исследование
крови на билирубин, АлАТ, АсАТ
·
В конце преджелтушного
периода -повышение уровня
трансаминаз;
·
В желтушном периоде:
повышение уровня трансаминаз
АлАТ, АсАТ; повышение уровня
общего билирубина за счет
прямой фракции.
Общий анализ мочи
Определение желчных пигментов
Общий анализ крови
лейкопения или нормальный
уровень лейкоцитов, лимфоцитоз
Кровь на ИФА
Анти - HAVJgM и анти-HEVJgM
Инструментальные исследования
УЗИ органов брюшной полости
При повторных болях в животе и при длительно сохраняющемся
желтушном синдроме.
154.
Диагностика и лечение кишечных инфекцийПРИНЦИПЫ НЕМЕДИКАМЕНТОЗНОГО И МЕДИКАМЕНТОЗНОГО
ЛЕЧЕНИЯ.
Немедикаментозное лечение (базисная терапия):
Режим: полупостельный на период разгара заболевания;
Диета: стол № 5, где сохраняется возрастная норма белков, жиров и углеводов, пища
должна быть приготовлена механически и химически щадящая, без экстрактивных
веществ, исключаются мясные бульоны, острые и пряные приправы, трудно
перевариваемая клетчатка.
Питье жидкости вода, морсы, компот; щелочная минеральная вода
Медикаментозное лечение:
дезинтоксикационная терапия – для легкой формы проводится энтерально: 5% раствор
глюкозы.
155.
Диагностика и лечение кишечных инфекцийОЦЕНКА ЭФФЕКТИВНОСТИ И БЕЗОПАСТНОСТИ ПРОВОДИМОГО
ЛЕЧЕНИЯ
Индикаторы эффективности лечения:
отсутствие интоксикации;
нормализация показателей билирубина, АлАТ;
нормализация размеров печени
156.
Диагностика и лечение кишечных инфекцийТАКТИКА ВЕДЕНИЯ ПАЦИЕНТОВ
Диспансеризация переболевших ОВГ А и Е осуществляется в кабинете
инфекционных заболеваний территориальной организации здравоохранения с
письменной рекомендацией лечащего врача, выдаваемой на руки больному;
Диспансерное наблюдение проводится за переболевшими ВГА,Е – три
месяца. Первый осмотр через 30 дней после выписки из стационара, повторный
— через 3 месяца. При отсутствии остаточных явлений и полной нормализации
печеночных проб реконвалесценты снимаются с учета. При наличии
остаточных явлений диспансерное наблюдение проводится до полного
выздоровления.
Лицам, перенесшим ОВГ, противопоказаны профилактические прививки в
течение шести месяцев после выписки из стационара, кроме (при наличии
показаний) противостолбнячного анатоксина и антирабической вакцины.
157.
Диагностика и лечение кишечных инфекцийПОКАЗАНИЯ К ОКАЗАНИЮ СПЕЦИАЛИЗИРОВАННОЙ
МЕДИЦИНСКОЙ ПОМОЩИ В СТАЦИОНАРНЫХ УСЛОВИЯХ
Показания для плановой госпитализации:
· дети из закрытых и других медицинских учреждений;
· по клиническим показаниям- легкие формы при наличии сопутствующей патологии печени и
желудочно-кишечного тракта;
· продолжительность желтухи более двух недель и ее нарастание;
Показания для экстренной госпитализации:
· дети до 5 лет, с наличием общих признаков опасностей (не может пить или сосать грудь, рвота
после каждого приема пищи и питья, судороги в анамнезе данного заболевания и летаргичен или без
сознания);
· среднетяжелые и тяжелые формы ВГА или ВГЕ

medicine
medicine








